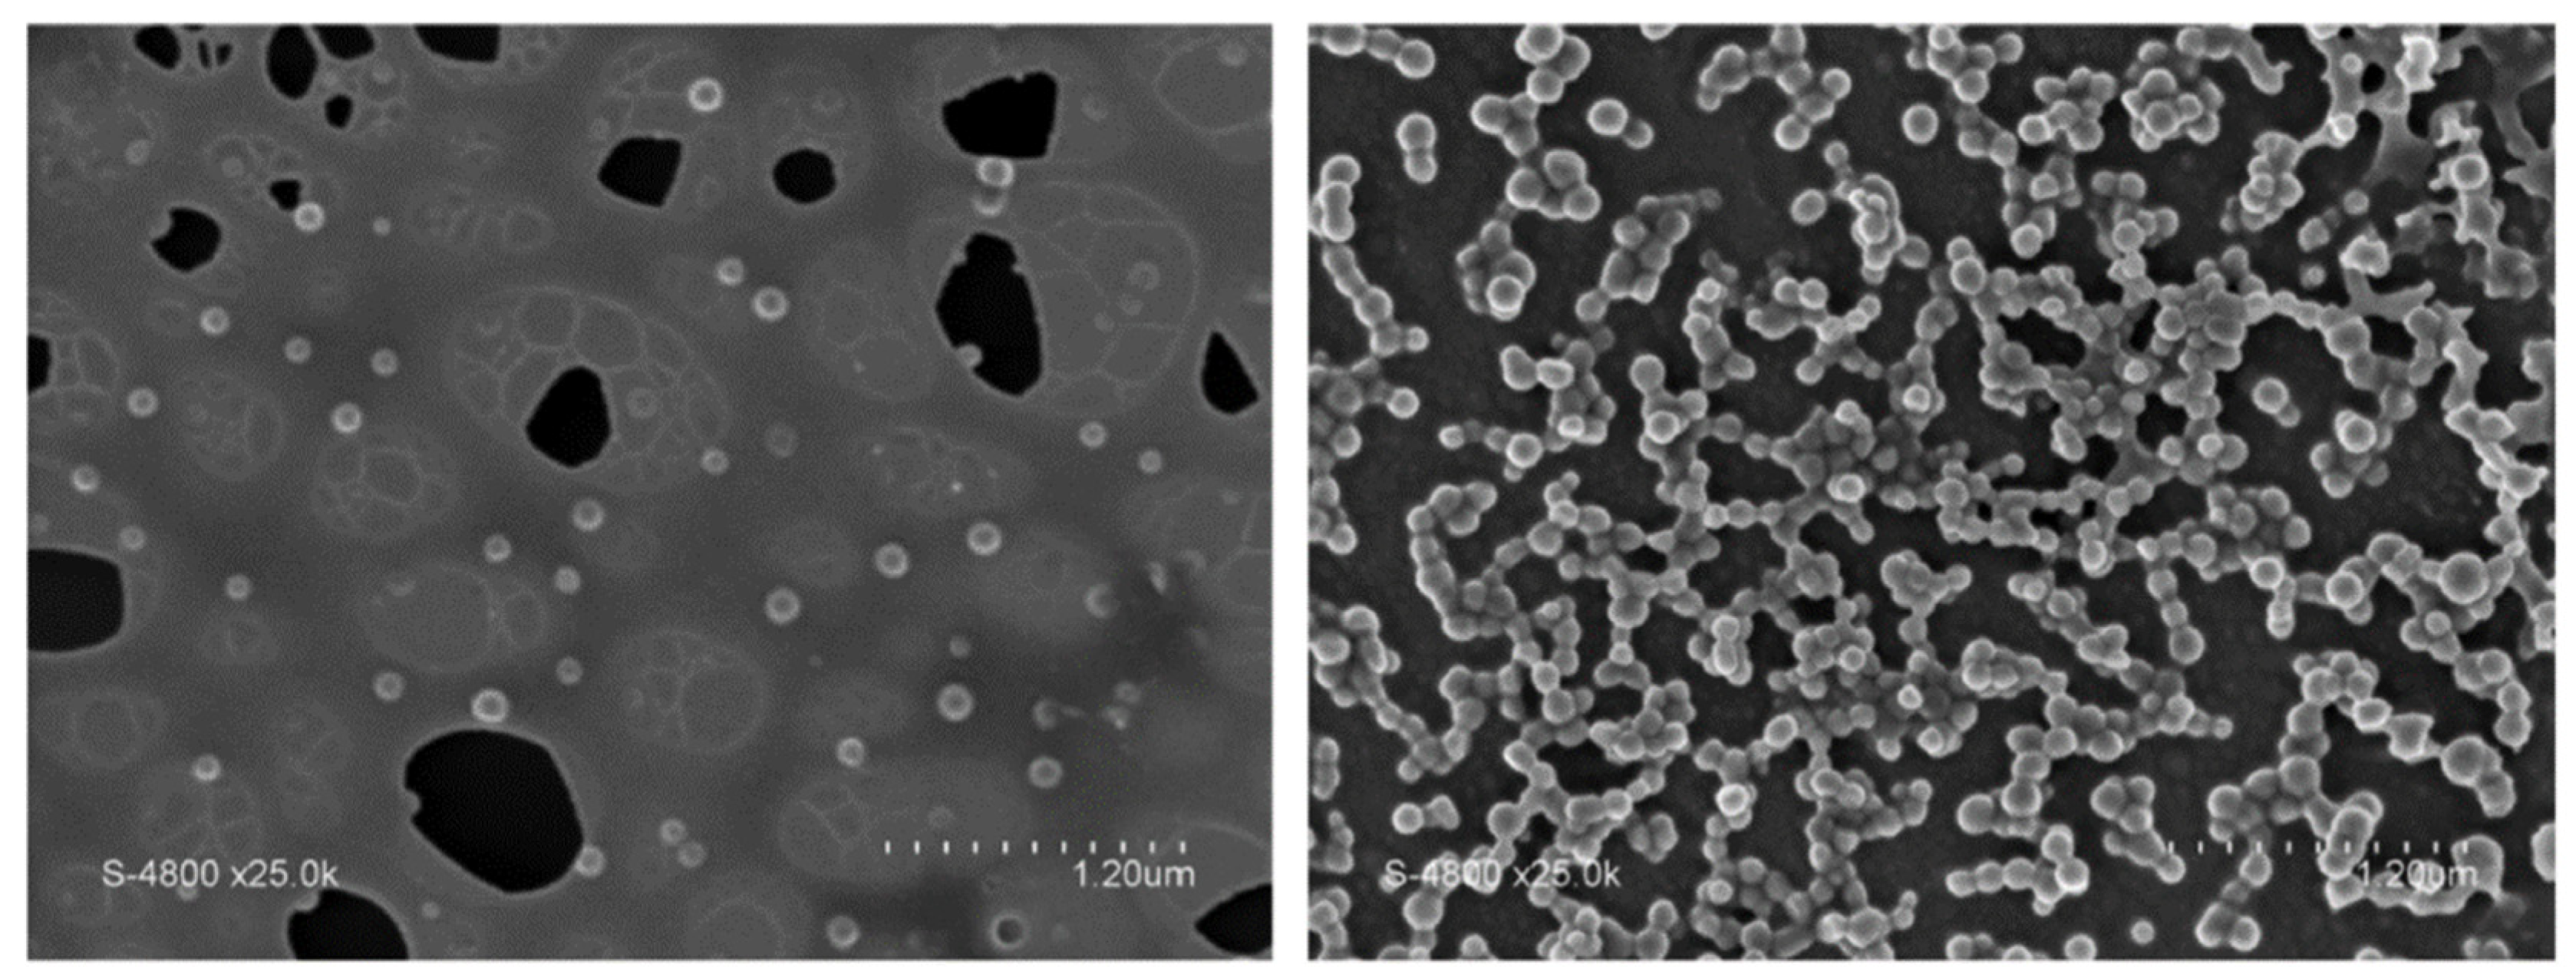
Energies 14 07003 g018

Destabilization of Boron-Based Compounds for Hydrogen Storage in the Solid-State: Recent Advances
Abstract
:1. Introduction
2. Overview
3. Destabilization Approaches
4. LiBH4
4.1. Destabilization by Additives
4.1.1. Boron-Containing Compounds
4.1.2. Aluminum-Containing Compounds
4.1.3. Intermetallic Compounds
4.1.4. Carbon-Based Materials
4.1.5. Polymers
4.1.6. Sulfides
4.1.7. Ti-Based Additives
4.1.8. MgH2 Reactive Hydride Composite
4.1.9. Other Dopants
4.2. Chemical Modification
4.3. Nanoconfinement
4.3.1. Carbon-Based Scaffolds
4.3.2. Aluminum-Based Scaffolds
4.3.3. Polymers
4.3.4. Other Scaffolds
4.3.5. Nanosizing
4.4. General Remarks
5. NaBH4
5.1. Additives
5.2. Chemical Modification
5.3. Nanosizing
5.4. General Remarks
6. Mg(BH4)2 and Ca(BH4)2
6.1. Additives
6.2. Chemical Modification
6.3. Nanoconfinement
6.4. General Remarks
7. Ammonia Borane
7.1. Additives
7.2. Chemical Modification
7.2.1. Monometallic Amidoboranes
7.2.2. Bimetallic Amidoboranes
7.2.3. Other Systems
7.3. Nanoconfinement
7.3.1. Silicon-Based Scaffolds
7.3.2. Carbon-Based Scaffolds
7.3.3. Metal Organic Frameworks
7.3.4. Polymers
7.3.5. Other Scaffolds
7.3.6. Nanosizing
7.4. General Remarks
8. Hydrazine Borane
8.1. Additives
8.2. Chemical Modification
8.2.1. Alkali Hydrazinidoboranes
8.2.2. Alkaline Earth Hydrazinidoboranes
8.3. General Remarks
9. Hydrazine Bisborane
10. Conclusions and Opportunities
Author Contributions
Funding
Conflicts of Interest
References
- Al-Ghussain, L. Global warming: Review on driving forces and mitigation. Environ. Prog. Sustain. Energy 2019, 38, 13–21. [Google Scholar] [CrossRef] [Green Version]
- Oliveira, A.M.; Beswick, R.R.; Yan, Y. A green hydrogen economy for a renewable energy society. Curr. Opin. Chem. Eng. 2021, 33, 100701. [Google Scholar] [CrossRef]
- Brandon, N.P.; Kurban, Z. Clean energy and the hydrogen economy. Phil. Trans. R. Soc. A 2017, 375, 1–17. [Google Scholar] [CrossRef]
- Abdalla, A.M.; Hossain, S.; Nisfindy, O.B.; Azad, A.T.; Dawood, M.; Azad, A.K. Hydrogen production, storage, transportation and key challenges with applications: A review. Energy Convers. Manag. 2018, 165, 602–627. [Google Scholar] [CrossRef]
- Moradi, R.; Groth, K.M. Hydrogen storage and delivery: Review of the state of the art technologies and risk and reliability analysis. Int. J. Hydrogen Energy 2019, 44, 12254–12269. [Google Scholar] [CrossRef]
- Sinigaglia, T.; Lewiski, F.; Santos Martins, M.E.; Mairesse Siluk, J.C. Production, storage, fuel stations of hydrogen and its utilization in automotive applications-a review. Int. J. Hydrogen Energy 2017, 42, 24597–24611. [Google Scholar] [CrossRef]
- Gupta, A.; Baron, G.V.; Perreault, P.; Lenaerts, S.; Ciocarlan, R.-G.; Cool, P.; Mileo, P.G.M.; Rogge, S.; Van Speybroeck, V.; Watson, G.; et al. Hydrogen clathrates: Next generation hydrogen storage materials. Energy Storage Mater. 2021, 41, 69–107. [Google Scholar] [CrossRef]
- Kojima, Y. Hydrogen storage materials for hydrogen and energy carriers. Int. J. Hydrogen Energy 2019, 44, 18179–18192. [Google Scholar] [CrossRef]
- Yu, X.; Tang, Z.; Sun, D.; Ouyang, L.; Zhu, M. Recent advances and remaining challenges of nanostructured materials for hydrogen storage applications. Prog. Mater. Sci. 2017, 88, 1–48. [Google Scholar] [CrossRef]
- Gangu, K.K.; Maddila, S.; Mukkamala, S.B.; Jonnalagadda, S.B. Characteristics of MOF, MWCNT and graphene containing materials for hydrogen storage: A review. J. Energy Chem. 2019, 30, 132–144. [Google Scholar] [CrossRef] [Green Version]
- Ren, J.; Musyoka, N.M.; Langmi, H.W.; Mathe, M.; Liao, S. Current research trends and perspectives on materials-based hydrogen storage solutions: A critical review. Int. J. Hydrogen Energy 2017, 42, 289–311. [Google Scholar] [CrossRef]
- Rao, P.C.; Yoon, M. Potential liquid-organic hydrogen carrier (LOHC) systems: A review on recent progress. Energies 2020, 13, 6040. [Google Scholar] [CrossRef]
- Niermann, M.; Timmerberg, S.; Drünert, S.; Kaltschmitt, M. Liquid organic hydrogen carriers and alternatives for international transport of renewable hydrogen. Renew. Sustain. Energy Rev. 2021, 135, 110171. [Google Scholar] [CrossRef]
- Aziz, M.; Wijayanta, A.T.; Nandiyanto, A.B.D. Ammonia as effective hydrogen storage: A review on production, storage and utilization. Energies 2020, 13, 3062. [Google Scholar] [CrossRef]
- Moussa, G.; Moury, R.; Demirci, U.B.; Şener, T.; Miele, P. Boron-based hydrides for chemical hydrogen storage. Int. J. Energy Res. 2013, 37, 825–842. [Google Scholar] [CrossRef]
- Umegaki, T.; Yan, J.M.; Zhang, X.B.; Shioyama, H.; Kuriyama, N.; Xu, Q. Boron- and nitrogen-based chemical hydrogen storage materials. Int. J. Hydrogen Energy 2009, 34, 2303–2311. [Google Scholar] [CrossRef]
- Abdelhamid, H.N. A review on hydrogen generation from the hydrolysis of sodium borohydride. Int. J. Hydrogen Energy 2021, 46, 726–765. [Google Scholar] [CrossRef]
- Li, H.; Yang, Q.; Chen, X.; Shore, S.G. Ammonia borane, past as prolog. J. Organomet. Chem. 2014, 751, 60–66. [Google Scholar] [CrossRef]
- Schlesinger, H.I.; Brown, H.C.; Hoekstra, H.R.; Rapp, L.R. Reactions of diborane with alkali metal hydrides and their addition compounds. new syntheses of borohydrides. Sodium and potassium borohydrides 1. J. Am. Chem. Soc. 1953, 75, 199–204. [Google Scholar] [CrossRef]
- Schlesinger, H.I.; Brown, H.C.; Finholt, A.E.; Gilbreath, J.R.; Hoekstra, H.R.; Hyde, E.K. Sodium borohydride, its hydrolysis and its use as a reducing agent and in the generation of hydrogen. J. Am. Chem. Soc. 1953, 75, 215–219. [Google Scholar] [CrossRef]
- Fakioglu, E.; Yürüm, Y.; Veziroglu, T.N. A review of hydrogen storage systems based on boron and its compounds. Int. J. Hydrogen Energy 2004, 29, 1371–1376. [Google Scholar] [CrossRef]
- Zhang, J.; Fisher, T.; Gore, J.; Hazra, D.; Ramachandran, P. Heat of reaction measurements of sodium borohydride alcoholysis and hydrolysis. Int. J. Hydrogen Energy 2006, 31, 2292–2298. [Google Scholar] [CrossRef]
- Nunes, H.X.; Silva, D.L.; Rangel, C.M.; Pinto, A.M.F.R. Rehydrogenation of sodium borates to close the NaBH4-H2 cycle: A review. Energies 2021, 14, 3567. [Google Scholar] [CrossRef]
- Le, T.T.; Pistidda, C.; Puszkiel, J.; Milanese, C.; Garroni, S.; Emmler, T.; Capurso, G.; Gizer, G.; Klassen, T.; Dornheim, M. Efficient synthesis of alkali borohydrides from mechanochemical reduction of borates using magnesium–aluminum-based waste. Metals 2019, 9, 1061. [Google Scholar] [CrossRef] [Green Version]
- Schlesinger, H.I.; Sanderson, R.T.; Burg, A.B. Metallo borohydrides. I. Aluminum borohydride. J. Am. Chem. Soc. 1940, 62, 3421–3425. [Google Scholar] [CrossRef]
- Burg, A.B.; Schlesinger, H.I. Metallo borohydrides. II. Beryllium borohydride. J. Am. Chem. Soc. 1940, 62, 3425–3429. [Google Scholar] [CrossRef]
- Schlesinger, H.I.; Brown, H.C. Metallo borohydrides. III. Lithium borohydride. J. Am. Chem. Soc. 1940, 62, 3429–3435. [Google Scholar] [CrossRef]
- Schlesinger, H.I.; Brown, H.C.; Schaeffer, G.W. The borohydrides of gallium. J. Am. Chem. Soc. 1943, 65, 1786–1787. [Google Scholar] [CrossRef]
- Schlesinger, H.I.; Brown, H.C. Uranium(IV) borohydride. J. Am. Chem. Soc. 1953, 75, 219–221. [Google Scholar] [CrossRef]
- Zhang, W.; Zhang, X.; Huang, Z.; Li, H.-W.; Gao, M.; Pan, H.; Liu, Y. Recent development of lithium borohydride-based materials for hydrogen storage. Adv. Energy Sustain. Res. 2021, 2, 2100073. [Google Scholar] [CrossRef]
- Orimo, S.I.; Nakamori, Y.; Eliseo, J.R.; Züttel, A.; Jensen, C.M. Complex hydrides for hydrogen storage. Chem. Rev. 2007, 107, 4111–4132. [Google Scholar] [CrossRef] [PubMed]
- Orimo, S.-I.; Nakamori, Y.; Ohba, N.; Miwa, K.; Aoki, M.; Towata, S.; Züttel, A. Experimental studies on intermediate compound of LiBH4. Appl. Phys. Lett. 2006, 89, 021920. [Google Scholar] [CrossRef]
- Orimo, S.; Nakamori, Y.; Kitahara, G.; Miwa, K.; Ohba, N.; Towata, S.; Züttel, A. Dehydriding and rehydriding reactions of LiBH4. J. Alloys Compd. 2005, 404–406, 427–430. [Google Scholar] [CrossRef]
- Matsunaga, T.; Buchter, F.; Mauron, P.; Bielman, M.; Nakamori, Y.; Orimo, S.; Ohba, N.; Miwa, K.; Towata, S.; Züttel, A. Hydrogen storage properties of Mg[BH4]2. J. Alloys Compd. 2008, 459, 583–588. [Google Scholar] [CrossRef]
- Li, H.-W.; Miwa, K.; Ohba, N.; Fujita, T.; Sato, T.; Yan, Y.; Towata, S.; Chen, M.W.; Orimo, S. Formation of an intermediate compound with a B12H12 cluster: Experimental and theoretical studies on magnesium borohydride Mg(BH4)2. Nanotechnology 2009, 20, 204013. [Google Scholar] [CrossRef] [PubMed]
- Miwa, K.; Aoki, M.; Noritake, T.; Ohba, N.; Nakamori, Y.; Towata, S.; Züttel, A.; Orimo, S. Thermodynamical stability of calcium borohydride Ca(BH4)2. Phys. Rev. B 2006, 74, 155122. [Google Scholar] [CrossRef]
- Kim, J.-H.; Shim, J.-H.; Cho, Y.W. On the reversibility of hydrogen storage in Ti- and Nb-catalyzed Ca(BH4)2. J. Power Sources 2008, 181, 140–143. [Google Scholar] [CrossRef]
- Demirci, U.B. Impact of H.I. Schlesinger’s discoveries upon the course of modern chemistry on B−(N−)H hydrogen carriers. Int. J. Hydrogen Energy 2017, 42, 21048–21062. [Google Scholar] [CrossRef]
- Shore, S.G.; Parry, R.W. The crystalline compound ammonia borane,1 H3NBH3. J. Am. Chem. Soc. 1955, 77, 6084–6085. [Google Scholar] [CrossRef]
- Ramachandran, P.V.; Gagare, P.D. Preparation of ammonia borane in high yield and purity, methanolysis, and regeneration. Inorg. Chem. 2007, 46, 7810–7817. [Google Scholar] [CrossRef]
- Demirci, U.B. Ammonia borane: An extensively studied, though not yet implemented, hydrogen carrier. Energies 2020, 13, 3071. [Google Scholar] [CrossRef]
- Alpaydin, C.Y.; Gülbay, S.K.; Colpan, C.O. A review on the catalysts used for hydrogen production from ammoniaborane. Int. J. Energy Res. 2020, 45, 3414–3434. [Google Scholar] [CrossRef]
- Demirci, U.B. About the technological readiness of the H2 generation by hydrolysis of B(−N)−H compounds. Energy Technol. 2018, 6, 470–486. [Google Scholar] [CrossRef] [Green Version]
- Brockman, A.; Zheng, Y.; Gore, J. A study of catalytic hydrolysis of concentrated ammonia borane solutions. Int. J. Hydrogen Energy 2010, 35, 7350–7356. [Google Scholar] [CrossRef]
- Chandra, M.; Xu, Q. Dissociation and hydrolysis of ammonia-borane with solid acids and carbon dioxide: An efficient hydrogen generation system. J. Power Sources 2006, 159, 855–860. [Google Scholar] [CrossRef]
- Li, H.; Yan, Y.; Feng, S.; Chen, Y.; Fan, H. Ammonia borane and its applications in the advanced energy technology. J. Energy Resour. Technol. 2021, 143. [Google Scholar] [CrossRef]
- Kantürk Figen, A.; Pişkin, M.B.; Coşkuner, B.; Imamoǧlu, V. Synthesis, structural characterization, and hydrolysis of Ammonia Borane (NH3BH3) as a hydrogen storage carrier. Int. J. Hydrogen Energy 2013, 38, 16215–16228. [Google Scholar] [CrossRef]
- Roy, B.; Pal, U.; Bishnoi, A.; O’Dell, L.A.; Sharma, P. Exploring the homopolar dehydrocoupling of ammonia borane by solid-state multinuclear NMR spectroscopy. Chem. Commun. 2021, 1887–1890. [Google Scholar] [CrossRef] [PubMed]
- Chen, X.; Zhao, J.C.; Shore, S.G. The roles of dihydrogen bonds in amine borane chemistry. Acc. Chem. Res. 2013, 46, 2666–2675. [Google Scholar] [CrossRef]
- Baitalow, F.; Baumann, J.; Wolf, G.; Jaenicke-Rößler, K.; Leitner, G. Thermal decomposition of B–N–H compounds investigated by using combined thermoanalytical methods. Thermochim. Acta 2002, 391, 159–168. [Google Scholar] [CrossRef]
- Hu, M.G.; Geanangel, R.A.; Wendlandt, W.W. The thermal decomposition of ammonia borane. Thermochim. Acta 1978, 23, 249–255. [Google Scholar] [CrossRef]
- Summerscales, O.T.; Gordon, J.C. Regeneration of ammonia borane from spent fuel materials. Dalt. Trans. 2013, 42, 10075–10084. [Google Scholar] [CrossRef] [PubMed]
- Frueh, S.; Kellett, R.; Mallery, C.; Molter, T.; Willis, W.S.; King’Ondu, C.; Suib, S.L. Pyrolytic decomposition of ammonia borane to boron nitride. Inorg. Chem. 2011, 50, 783–792. [Google Scholar] [CrossRef] [PubMed]
- Kostoglou, N.; Polychronopoulou, K.; Rebholz, C. Thermal and chemical stability of hexagonal boron nitride (h-BN) nanoplatelets. Vacuum 2015, 112, 42–45. [Google Scholar] [CrossRef]
- Sit, V.; Geanangel, R.A.; Wendlandt, W.W. The thermal dissociation of NH3BH3. Thermochim. Acta 1987, 113, 379–382. [Google Scholar] [CrossRef]
- Sutton, A.D.; Burrell, A.K.; Dixon, D.A.; Garner, E.B.; Gordon, J.C.; Nakagawa, T.; Ott, K.C.; Robinson, J.P.; Vasiliu, M. Regeneration of ammonia borane spent fuel by direct reaction with hydrazine and liquid ammonia. Science 2011, 331, 1426–1429. [Google Scholar] [CrossRef] [PubMed] [Green Version]
- Schlesinger, H.I.; Burg, A.B. Hydrides of boron. VIII. The structure of the diammoniate of diborane and its relation to the structure of diborane. J. Am. Chem. Soc. 1938, 60, 290–299. [Google Scholar] [CrossRef]
- Myers, A.G.; Yang, B.H.; Kopecky, D.J. Lithium amidotrihydroborate, a powerful new reductant. Transformation of tertiary amides to primary alcohols. Tetrahedron Lett. 1996, 37, 3623–3626. [Google Scholar] [CrossRef] [Green Version]
- Diyabalanage, H.V.K.; Shrestha, R.P.; Semelsberger, T.A.; Scott, B.L.; Bowden, M.E.; Davis, B.L.; Burrell, A.K. Calcium amidotrihydroborate: A hydrogen storage material. Angew. Chemie–Int. Ed. 2007, 46, 8995–8997. [Google Scholar] [CrossRef] [PubMed]
- Xiong, Z.; Yong, C.K.; Wu, G.; Chen, P.; Shaw, W.; Karkamkar, A.; Autrey, T.; Jones, M.O.; Johnson, S.R.; Edwards, P.P.; et al. High-capacity hydrogen storage in lithium and sodium amidoboranes. Nat. Mater. 2008, 7, 138–141. [Google Scholar] [CrossRef] [PubMed]
- Owarzany, R.; Leszczyński, P.J.; Fijalkowski, K.J.; Grochala, W. Mono- and bimetalic amidoboranes. Crystals 2016, 6, 88. [Google Scholar] [CrossRef]
- Staubitz, A.; Robertson, A.P.M.; Sloan, M.E.; Manners, I. Amine– and phosphine–borane adducts: New interest in old molecules. Chem. Rev. 2010, 110, 4023–4078. [Google Scholar] [CrossRef]
- Goubeau, J.; Ricker, E. Borinhydrazin und seine pyrolyseprodukte. Z. Anorg. Allg. Chem. 1961, 310, 123–142. [Google Scholar] [CrossRef]
- Yurderi, M.; Top, T.; Bulut, A.; Kanberoglu, G.S.; Kaya, M.; Zahmakiran, M. Complete dehydrogenation of hydrazine borane on manganese oxide nanorod-supported Ni@Ir core–shell nanoparticles. Inorg. Chem. 2020, 59, 9728–9738. [Google Scholar] [CrossRef]
- Lu, Z.-H.; Yao, Q.; Zhang, Z.; Yang, Y.; Chen, X. Nanocatalysts for hydrogen generation from ammonia borane and hydrazine borane. J. Nanomater. 2014, 2014, 1–11. [Google Scholar] [CrossRef]
- Hügle, T.; Kühnel, M.F.; Lentz, D. Hydrazine borane: A promising hydrogen storage material. J. Am. Chem. Soc. 2009, 131, 7444–7446. [Google Scholar] [CrossRef] [PubMed]
- Moury, R.; Moussa, G.; Demirci, U.B.; Hannauer, J.; Bernard, S.; Petit, E.; Van Der Lee, A.; Miele, P. Hydrazine borane: Synthesis, characterization, and application prospects in chemical hydrogen storage. Phys. Chem. Chem. Phys. 2012, 14, 1768–1777. [Google Scholar] [CrossRef] [PubMed]
- Gunderloy, F.C.; Spielvogel, B.; Parry, R.W. Hydrazine-mono- and -bisborane. Inorg. Synth. 1967, 9, 13–16. [Google Scholar] [CrossRef]
- Pylypko, S.; Petit, E.; Yot, P.G.; Salles, F.; Cretin, M.; Miele, P.; Demirci, U.B. Key study on the potential of hydrazine bisborane for solid- and liquid-state chemical hydrogen storage. Inorg. Chem. 2015, 54, 4574–4583. [Google Scholar] [CrossRef] [PubMed]
- Sun, W.; Gu, Q.; Guo, Y.; Guo, Z.; Liu, H.; Yu, X. Hydrazine bisborane as a promising material for chemical hydrogen storage. Int. J. Hydrogen Energy 2011, 36, 13640–13644. [Google Scholar] [CrossRef]
- Harris, P.M.; Meibohm, E.P. The crystal structure of lithium borohydride LiBH4. J. Am. Chem. Soc. 1947, 69, 1231–1232. [Google Scholar] [CrossRef]
- El Kharbachi, A.; Pinatel, E.; Nuta, I.; Baricco, M. A thermodynamic assessment of LiBH4. Calphad Comput. Coupling Phase Diagrams Thermochem. 2012, 39, 80–90. [Google Scholar] [CrossRef] [Green Version]
- Züttel, A.; Rentsch, S.; Fischer, P.; Wenger, P.; Sudan, P.; Mauron, P.; Emmenegger, C. Hydrogen storage properties of LiBH4. J. Alloys Compd. 2003, 356–357, 515–520. [Google Scholar] [CrossRef]
- Pitt, M.P.; Paskevicius, M.; Brown, D.H.; Sheppard, D.A.; Buckley, C.E. Thermal stability of Li2B12H12 and its role in the decomposition of LiBH4. J. Am. Chem. Soc. 2013, 135, 6930–6941. [Google Scholar] [CrossRef]
- Friedrichs, O.; Remhof, A.; Hwang, S.J.; Züttel, A. Role of Li2B12H12 for the formation and decomposition of LiBH4. Chem. Mater. 2010, 22, 3265–3268. [Google Scholar] [CrossRef]
- Tu, G.; Xiao, X.; Qin, T.; Jiang, Y.; Li, S.; Ge, H.; Chen, L. Significantly improved de/rehydrogenation properties of lithium borohydride modified with hexagonal boron nitride. RSC Adv. 2015, 5, 51110–51115. [Google Scholar] [CrossRef]
- Zhu, J.; Wang, H.; Cai, W.; Liu, J.; Ouyang, L.; Zhu, M. The milled LiBH4/h-BN composites exhibiting unexpected hydrogen storage kinetics and reversibility. Int. J. Hydrogen Energy 2017, 42, 15790–15798. [Google Scholar] [CrossRef]
- Cai, W.; Hou, J.; Tao, P.; Yang, Y. An insight into the dehydrogenation behaviour of LiBH4 exhibiting remarkable kinetics enhanced by nanostructured h-BN. J. Alloys Compd. 2018, 750, 443–450. [Google Scholar] [CrossRef]
- Zhu, J.; Wang, H.; Liu, J.; Ouyang, L.; Zhu, M. Achieving high dehydrogenation kinetics and reversibility of LiBH4 by adding nanoporous h-BN to destabilize LiH. J. Phys. Chem. C 2018, 122, 23336–23344. [Google Scholar] [CrossRef]
- Muthu, R.N.; Rajashabala, S.; Kannan, R. Hydrogen storage performance of lithium borohydride decorated activated hexagonal boron nitride nanocomposite for fuel cell applications. Int. J. Hydrogen Energy 2017, 42, 15586–15596. [Google Scholar] [CrossRef]
- Tu, G.; Xiao, X.; Jiang, Y.; Qin, T.; Li, S.; Ge, H.; Wang, Q.; Chen, L. Composite cooperative enhancement on the hydrogen desorption kinetics of LiBH4 by co-doping with NbCl5 and hexagonal BN. Int. J. Hydrogen Energy 2015, 40, 10527–10535. [Google Scholar] [CrossRef]
- Ma, Y.; Li, Y.; Liu, T.; Zhao, X.; Zhang, L.; Han, S.; Wang, Y. Enhanced hydrogen storage properties of LiBH4 generated using a porous Li3BO3 catalyst. J. Alloys Compd. 2016, 689, 187–191. [Google Scholar] [CrossRef]
- Li, Z.; Gao, M.; Gu, J.; Xian, K.; Yao, Z.; Shang, C.; Liu, Y.; Guo, Z.; Pan, H. In situ introduction of Li3BO3 and NbH leads to superior cyclic stability and kinetics of a LiBH4-based hydrogen storage system. ACS Appl. Mater. Interfaces 2020, 12, 893–903. [Google Scholar] [CrossRef] [PubMed]
- Wu, Y.; Jiang, X.; Chen, J.; Qi, Y.; Zhang, Y.; Fu, H.; Zheng, J.; Li, X. Boric acid destabilized lithium borohydride with a 5.6 wt% dehydrogenation capacity at moderate temperatures. Dalt. Trans. 2017, 46, 4499–4503. [Google Scholar] [CrossRef] [PubMed]
- Roedern, E.; Hansen, B.R.S.; Ley, M.B.; Jensen, T.R. Effect of eutectic melting, reactive hydride composites, and nanoconfinement on decomposition and reversibility of LiBH4-KBH4. J. Phys. Chem. C 2015, 119, 25818–25825. [Google Scholar] [CrossRef]
- Frommen, C.; Heere, M.; Riktor, M.D.; Sørby, M.H.; Hauback, B.C. Hydrogen storage properties of rare earth (RE) borohydrides (RE = La, Er) in composite mixtures with LiBH4 and LiH. J. Alloys Compd. 2015, 645, S155–S159. [Google Scholar] [CrossRef] [Green Version]
- Liu, Y.; Reed, D.; Paterakis, C.; Contreras Vasquez, L.; Baricco, M.; Book, D. Study of the decomposition of a 0.62LiBH4–0.38NaBH4 mixture. Int. J. Hydrogen Energy 2017, 42, 22480–22488. [Google Scholar] [CrossRef]
- Wang, L.; Rawal, A.; Quadir, M.Z.; Aguey-Zinsou, K.F. Nanoconfined lithium aluminium hydride (LiAlH4) and hydrogen reversibility. Int. J. Hydrogen Energy 2017, 42, 14144–14153. [Google Scholar] [CrossRef]
- He, Q.; Zhu, D.; Wu, X.; Dong, D.; Xu, M.; Tong, Z. Hydrogen desorption properties of LiBH4/xLiAlH4 (x = 0.5, 1, 2) composites. Molecules 2019, 24, 1861. [Google Scholar] [CrossRef] [Green Version]
- Gu, R.; Wang, C.Y.; Liu, D.M.; Gao, C.; Li, Y.T.; Si, T.Z. De-/rehydrogenation properties and reaction mechanisms of 4LiBH4-LiAlH4-MgF2 system. Int. J. Hydrogen Energy 2015, 40, 10536–10541. [Google Scholar] [CrossRef]
- Thaweelap, N.; Utke, R. Dehydrogenation kinetics and reversibility of LiAlH4–LiBH4 doped with Ti-based additives and MWCNT. J. Phys. Chem. Solids 2016, 98, 149–155. [Google Scholar] [CrossRef]
- Li, Z.; Wang, H.; Ouyang, L.; Liu, J.; Zhu, M. Enhanced dehydrogenation of LiBH4·NH3–LiAlH4 composites. Int. J. Hydrogen Energy 2017, 42, 22406–22410. [Google Scholar] [CrossRef]
- Halim Yap, F.A.; Ali, N.A.; Idris, N.H.; Ismail, M. Catalytic effect of MgFe2O4 on the hydrogen storage properties of Na3AlH6–LiBH4 composite system. Int. J. Hydrogen Energy 2018, 43, 20882–20891. [Google Scholar] [CrossRef]
- Liu, H.; Wang, X.; Zhou, H.; Gao, S.; Ge, H.; Li, S.; Yan, M. Improved hydrogen desorption properties of LiBH4 by AlH3 addition. Int. J. Hydrogen Energy 2016, 41, 22118–22127. [Google Scholar] [CrossRef]
- Zhu, J.; Mao, Y.; Wang, H.; Liu, J.; Ouyang, L.; Zhu, M. Reaction route optimized LiBH4 for high reversible capacity hydrogen storage by tunable surface-modified AlN. ACS Appl. Energy Mater. 2020, 3, 11964–11973. [Google Scholar] [CrossRef]
- Meggouh, M.; Grant, D.M.; Deavin, O.; Brunelli, M.; Hansen, T.C.; Walker, G.S. Investigation of the dehydrogenation behavior of the 2LiBH4:CaNi5 multicomponent hydride system. Int. J. Hydrogen Energy 2015, 40, 2989–2996. [Google Scholar] [CrossRef]
- Liu, D.M.; Tan, Q.J.; Gao, C.; Sun, T.; Li, Y.T. Reversible hydrogen storage properties of LiBH4 combined with hydrogenated Mg11CeNi alloy. Int. J. Hydrogen Energy 2015, 40, 6600–6605. [Google Scholar] [CrossRef]
- Yang, L.; Zhao, S.; Liu, D.; Li, Y.; Si, T. Hydrogen storage properties and reactive mechanism of LiBH4/Mg10YNi-H composite. Mater. Res. 2019, 22, 1–6. [Google Scholar] [CrossRef] [Green Version]
- Zhang, X.; Zhang, L.; Zhang, W.; Ren, Z.; Huang, Z.; Hu, J.; Gao, M.; Pan, H.; Liu, Y. Nano-synergy enables highly reversible storage of 9.2 wt% hydrogen at mild conditions with lithium borohydride. Nano Energy 2021, 83, 105839. [Google Scholar] [CrossRef]
- Xu, J.; Li, Y.; Cao, J.; Meng, R.; Wang, W.; Chen, Z. Preparation of graphene-supported highly dispersed nickel nanoparticles for the improved generation of hydrogen from ball-milled LiBH4. Catal. Sci. Technol. 2015, 5, 1821–1828. [Google Scholar] [CrossRef]
- Xu, G.; Zhang, W.; Zhang, Y.; Zhao, X.; Wen, P.; Ma, D. Fe3O4 nanoclusters highly dispersed on a porous graphene support as an additive for improving the hydrogen storage properties of LiBH4. RSC Adv. 2018, 8, 19353–19361. [Google Scholar] [CrossRef] [Green Version]
- Zhang, L.; Zheng, J.; Xiao, X.; Wang, X.; Huang, X.; Liu, M.; Wang, Q.; Chen, L. A new strategy to remarkably improve the low-temperature reversible hydrogen desorption performances of LiBH4 by compositing with fluorographene. Int. J. Hydrogen Energy 2017, 42, 20046–20055. [Google Scholar] [CrossRef]
- Zhang, W.; Xu, G.; Chen, L.; Pan, S.; Jing, X.; Wang, J.; Han, S. Enhanced hydrogen storage performances of LiBH4 modified with three-dimensional porous fluorinated graphene. Int. J. Hydrogen Energy 2017, 42, 15262–15270. [Google Scholar] [CrossRef]
- Wang, K.; Kang, X.; Ren, J.; Wang, P. Nanostructured graphite-induced destabilization of LiBH4 for reversible hydrogen storage. J. Alloys Compd. 2016, 685, 242–247. [Google Scholar] [CrossRef]
- Lai, Q.; Quadir, M.Z.; Aguey-Zinsou, K.F. LiBH4 electronic destabilization with nickel(II) phthalocyanine—Leading to a reversible hydrogen storage system. ACS Appl. Energy Mater. 2018, 1, 6824–6832. [Google Scholar] [CrossRef]
- Zhou, H.; Wang, X.H.; Liu, H.Z.; Gao, S.C.; Yan, M. Improved hydrogen storage properties of LiBH4 confined with activated charcoal by ball milling. Rare Met. 2019, 38, 321–326. [Google Scholar] [CrossRef]
- Cai, R.; Sun, L.X.; Xu, F.; Zou, Y.J.; Chu, H.L. LiBH4 confined in nitrogen-doped ordered mesoporous carbons for hydrogen storage. Mater. Sci. Forum 2016, 852, 858–863. [Google Scholar] [CrossRef]
- Meng, X.H.; Wan, C.B.; Wang, Y.T.; Ju, X. Porous Ni@C derived from bimetallic Metal–Organic Frameworks and its application for improving LiBH4 dehydrogenation. J. Alloys Compd. 2018, 735, 1637–1647. [Google Scholar] [CrossRef]
- Vellingiri, L.; Annamalai, K.; Kandasamy, R.; Kombiah, I. Single-walled carbon nanotubes/lithium borohydride composites for hydrogen storage: Role of: In situ formed LiB(OH)4, Li2CO3 and LiBO2 by oxidation and nitrogen annealing. RSC Adv. 2019, 9, 31483–31496. [Google Scholar] [CrossRef] [Green Version]
- Bao, Q.W.; Pan, W.Y.; Liu, H.; Liu, B.H.; Li, Z.P. Reversible hydrogen release and uptake for composites of LiBH4 with the conjugated polymer poly(p-phenylene). Int. J. Hydrogen Energy 2016, 41, 1027–1034. [Google Scholar] [CrossRef]
- Ding, Z.; Ma, Y.; Peng, D.; Zhang, L.; Zhao, Y.; Li, Y.; Han, S. Effects of the hierarchical pyrolysis polyaniline on reversible hydrogen storage of LiBH4. Prog. Nat. Sci. Mater. Int. 2018, 28, 529–533. [Google Scholar] [CrossRef]
- Zhao, Y.; Liu, Y.; Liu, H.; Kang, H.; Cao, K.; Wang, Q.; Zhang, C.; Wang, Y.; Yuan, H.; Jiao, L. Improved dehydrogenation performance of LiBH4 by 3D hierarchical flower-like MoS2 spheres additives. J. Power Sources 2015, 300, 358–364. [Google Scholar] [CrossRef]
- Wang, J.; Wang, Z.; Li, Y.; Ke, D.; Lin, X.; Han, S.; Ma, M. Effect of nano-sized Ce2S3 on reversible hydrogen storage properties of LiBH4. Int. J. Hydrogen Energy 2016, 41, 13156–13162. [Google Scholar] [CrossRef]
- Dolotko, O.; Gupta, S.; Kobayashi, T.; McDonald, E.; Hlova, I.; Majzoub, E.; Balema, V.P.; Pruski, M.; Pecharsky, V.K. Mechanochemical reactions and hydrogen storage capacities in MBH4–SiS2 systems (M[dbnd]Li or Na). Int. J. Hydrogen Energy 2019, 44, 7381–7391. [Google Scholar] [CrossRef] [Green Version]
- Bidabadi, A.S.; Varin, R.A.; Polanski, M.; Stobinski, L. Mechano-chemical activation of the (3LiBH4 + TiF3) system, its dehydrogenation behavior and the effects of ultrafine filamentary Ni and graphene additives. RSC Adv. 2016, 6, 93245–93258. [Google Scholar] [CrossRef]
- Lai, Q.; Milanese, C.; Aguey-Zinsou, K.F. Stabilization of nanosized borohydrides for hydrogen storage: Suppressing the melting with TiCl3 doping. ACS Appl. Energy Mater. 2018, 1, 421–430. [Google Scholar] [CrossRef]
- Fan, Y.; Chen, D.; Liu, X.; Fan, G.; Liu, B. Improving the hydrogen storage performance of lithium borohydride by Ti3C2 MXene. Int. J. Hydrogen Energy 2019, 44, 29297–29303. [Google Scholar] [CrossRef]
- Bösenberg, U.; Doppiu, S.; Mosegaard, L.; Barkhordarian, G.; Eigen, N.; Borgschulte, A.; Jensen, T.R.; Cerenius, Y.; Gutfleisch, O.; Klassen, T.; et al. Hydrogen sorption properties of MgH2-LiBH4 composites. Acta Mater. 2007, 55, 3951–3958. [Google Scholar] [CrossRef]
- Ding, Z.; Lu, Y.; Li, L.; Shaw, L. High reversible capacity hydrogen storage through nano-LiBH4 + nano-MgH2 system. Energy Storage Mater. 2019, 20, 24–35. [Google Scholar] [CrossRef]
- Ding, Z.; Shaw, L. Enhancement of hydrogen desorption from nanocomposite prepared by ball milling MgH2 with in situ aerosol spraying LiBH4. ACS Sustain. Chem. Eng. 2019, 7, 15064–15072. [Google Scholar] [CrossRef]
- Ding, Z.; Zhao, X.; Shaw, L.L. Reaction between LiBH4 and MgH2 induced by high-energy ball milling. J. Power Sources 2015, 293, 236–245. [Google Scholar] [CrossRef] [Green Version]
- Thiangviriya, S.; Utke, R. Improvement of dehydrogenation kinetics of 2LiBH4-MgH2 composite by doping with activated carbon nanofibers. Int. J. Hydrogen Energy 2016, 41, 2797–2806. [Google Scholar] [CrossRef]
- Plerdsranoy, P.; Chanthee, S.; Utke, R. Compaction of LiBH4-MgH2 doped with MWCNTs-TiO2 for reversible hydrogen storage. Int. J. Hydrogen Energy 2017, 42, 978–986. [Google Scholar] [CrossRef]
- Peng, D.; Li, Y.; Liu, Y.; Zhang, L.; Zhang, H.; Ding, Z.; Han, S. Effect of LiBH4 on hydrogen storage properties of magnesium hydride-carbon composite. J. Alloys Compd. 2017, 711, 104–110. [Google Scholar] [CrossRef]
- Thaweelap, N.; Thongtan, P.; Sitthiwet, C.; Thiangviriya, S.; Eiamlamai, P.; Utke, R. Hydrogen sorption, kinetics, reversibility, and reaction mechanisms of MgH2-xLiBH4 doped with activated carbon nanofibers for reversible hydrogen storage based laboratory powder and tank scales. Int. J. Hydrogen Energy 2017, 42, 24915–24926. [Google Scholar] [CrossRef]
- Zhou, H.; Liu, H.Z.; Xu, L.; Gao, S.C.; Wang, X.H.; Yan, M. Hydrogen storage properties of Nb-compounds-catalyzed LiBH4–MgH2. Rare Met. 2017, 36, 723–728. [Google Scholar] [CrossRef]
- Cheng, C.; Chen, M.; Xiao, X.; Huang, X.; Zheng, J.; Chen, L. Superior reversible hydrogen storage properties and mechanism of LiBH4-MgH2-Al doped with NbF5 additive. J. Phys. Chem. C 2018, 122, 7613–7620. [Google Scholar] [CrossRef]
- Puszkiel, J.A.; Gennari, F.C.; Larochette, P.A.; Ramallo-López, J.M.; Vainio, U.; Karimi, F.; Pranzas, P.K.; Troiani, H.; Pistidda, C.; Jepsen, J.; et al. Effect of Fe additive on the hydrogenation-dehydrogenation properties of 2LiH + MgB2/2LiBH4 + MgH2 system. J. Power Sources 2015, 284, 606–616. [Google Scholar] [CrossRef]
- Zhang, J.; Li, P.; Wan, Q.; Zhai, F.; Volinsky, A.A.; Qu, X. Superior destabilization effects of LiBH4 with the addition of nano-sized nickel ferrite NiFe2O4. RSC Adv. 2015, 5, 81212–81219. [Google Scholar] [CrossRef]
- Zhao, S.X.; Wang, C.Y.; Liu, D.M.; Tan, Q.J.; Li, Y.T.; Si, T.Z. Destabilization of LiBH4 by SrF2 for reversible hydrogen storage. Int. J. Hydrogen Energy 2018, 43, 5098–5103. [Google Scholar] [CrossRef]
- Kumari, P.; Sharma, K.; Agarwal, S.; Awasthi, K.; Ichikawa, T.; Kumar, M.; Jain, A. The destabilization of LiBH4 through the addition of Bi2Se3 nanosheets. Int. J. Hydrogen Energy 2020, 45, 23947–23953. [Google Scholar] [CrossRef]
- Wang, H.; Cao, H.; Wu, G.; He, T.; Chen, P. The improved hydrogen storage performances of the multi-component composite: 2Mg(NH2)2-3LiH-LiBH4. Energies 2015, 8, 6898–6909. [Google Scholar] [CrossRef] [Green Version]
- Liu, L.; Wu, G.; Chen, W.; Xiong, Z.; He, T.; Chen, P. Synthesis and hydrogen storage properties of lithium borohydride urea complex. Int. J. Hydrogen Energy 2015, 40, 429–434. [Google Scholar] [CrossRef]
- Wu, R.; Ren, Z.; Zhang, X.; Lu, Y.; Li, H.; Gao, M.; Pan, H.; Liu, Y. Nanosheet-like lithium borohydride hydrate with 10 wt % hydrogen release at 70°C as a chemical hydrogen storage candidate. J. Phys. Chem. Lett. 2019, 10, 1872–1877. [Google Scholar] [CrossRef] [PubMed]
- Richter, B.; Ravnsbæk, D.B.; Sharma, M.; Spyratou, A.; Hagemann, H.; Jensen, T.R. Fluoride substitution in LiBH4; Destabilization and decomposition. Phys. Chem. Chem. Phys. 2017, 19, 30157–30165. [Google Scholar] [CrossRef] [PubMed]
- Lai, Q.; Yang, Y.; Aguey-Zinsou, K.F. Nanoconfinement of borohydrides in hollow carbon spheres: Melt infiltration versus solvent impregnation for enhanced hydrogen storage. Int. J. Hydrogen Energy 2019, 44, 23225–23238. [Google Scholar] [CrossRef]
- Suwarno Ngene,, P.; Nale, A.; Eggenhuisen, T.M.; Oschatz, M.; Embs, J.P.; Remhof, A.; De Jongh, P.E. Confinement effects for lithium borohydride: Comparing silica and carbon scaffolds. J. Phys. Chem. C 2017, 121, 4197–4205. [Google Scholar] [CrossRef] [PubMed]
- Wu, R.; Zhang, X.; Liu, Y.; Zhang, L.; Hu, J.; Gao, M.; Pan, H. A unique double-layered carbon nanobowl-confined lithium borohydride for highly reversible hydrogen storage. Small 2020, 16, 1–9. [Google Scholar] [CrossRef] [PubMed]
- Wang, S.; Gao, M.; Xian, K.; Li, Z.; Shen, Y.; Yao, Z.; Liu, Y.; Pan, H. LiBH4 nanoconfined in porous hollow carbon nanospheres with high loading, low dehydrogenation temperature, superior kinetics, and favorable reversibility. ACS Appl. Energy Mater. 2020, 3, 3928–3938. [Google Scholar] [CrossRef]
- Shao, J.; Xiao, X.; Fan, X.; Huang, X.; Zhai, B.; Li, S.; Ge, H.; Wang, Q.; Chen, L. Enhanced hydrogen storage capacity and reversibility of LiBH4 nanoconfined in the densified zeolite-templated carbon with high mechanical stability. Nano Energy 2015, 15, 244–255. [Google Scholar] [CrossRef]
- Guo, L.; Li, Y.; Ma, Y.; Liu, Y.; Peng, D.; Zhang, L.; Han, S. Enhanced hydrogen storage capacity and reversibility of LiBH4 encapsulated in carbon nanocages. Int. J. Hydrogen Energy 2017, 42, 2215–2222. [Google Scholar] [CrossRef]
- Xian, K.; Nie, B.; Li, Z.; Gao, M.; Li, Z.; Shang, C.; Liu, Y.; Guo, Z.; Pan, H. TiO2 decorated porous carbonaceous network structures offer confinement, catalysis and thermal conductivity for effective hydrogen storage of LiBH4. Chem. Eng. J. 2021, 407, 127156. [Google Scholar] [CrossRef]
- Gasnier, A.; Gennari, F.C. Graphene entanglement in a mesoporous resorcinol-formaldehyde matrix applied to the nanoconfinement of LiBH4 for hydrogen storage. RSC Adv. 2017, 7, 27905–27912. [Google Scholar] [CrossRef] [Green Version]
- Gasnier, A.; Luguet, M.; Pereira, A.G.; Troiani, H.; Zampieri, G.; Gennari, F.C. Entanglement of N-doped graphene in resorcinol-formaldehyde: Effect over nanoconfined LiBH4 for hydrogen storage. Carbon N. Y. 2019, 147, 284–294. [Google Scholar] [CrossRef]
- Gasnier, A.; Amica, G.; Juan, J.; Troiani, H.; Gennari, F.C. N-Doped graphene-rich aerogels decorated with nickel and cobalt nanoparticles: Effect on hydrogen storage properties of nanoconfined LiBH4. J. Phys. Chem. C 2019, 124, 115–125. [Google Scholar] [CrossRef]
- Thiangviriya, S.; Utke, R. LiBH4 nanoconfined in activated carbon nanofiber for reversible hydrogen storage. Int. J. Hydrogen Energy 2015, 40, 4167–4174. [Google Scholar] [CrossRef]
- Plerdsranoy, P.; Kaewsuwan, D.; Chanlek, N.; Utke, R. Effects of specific surface area and pore volume of activated carbon nanofibers on nanoconfinement and dehydrogenation of LiBH4. Int. J. Hydrogen Energy 2017, 42, 6189–6201. [Google Scholar] [CrossRef]
- Surrey, A.; Bonatto Minella, C.; Fechler, N.; Antonietti, M.; Grafe, H.J.; Schultz, L.; Rellinghaus, B. Improved hydrogen storage properties of LiBH4 via nanoconfinement in micro- and mesoporous aerogel-like carbon. Int. J. Hydrogen Energy 2016, 41, 5540–5548. [Google Scholar] [CrossRef]
- Sitthiwet, C.; Thiangviriya, S.; Thaweelap, N.; Meethom, S.; Kaewsuwan, D.; Chanlek, N.; Utke, R. Hydrogen sorption and permeability of compacted LiBH4 nanoconfined into activated carbon nanofibers impregnated with TiO2. J. Phys. Chem. Solids 2017, 110, 344–353. [Google Scholar] [CrossRef]
- Zhou, H.; Zhang, L.; Gao, S.; Liu, H.; Xu, L.; Wang, X.; Yan, M. Hydrogen storage properties of activated carbon confined LiBH4 doped with CeF3 as catalyst. Int. J. Hydrogen Energy 2017, 42, 23010–23017. [Google Scholar] [CrossRef]
- Sofianos, M.V.; Sheppard, D.A.; Silvester, D.S.; Lee, J.; Paskevicius, M.; Humphries, T.D.; Buckley, C.E. Electrochemical synthesis of highly ordered porous Al scaffolds melt-infiltrated with LiBH4 for hydrogen storage. J. Electrochem. Soc. 2018, 165, D37–D42. [Google Scholar] [CrossRef]
- Sofianos, M.V.; Sheppard, D.A.; Ianni, E.; Humphries, T.D.; Rowles, M.R.; Liu, S.; Buckley, C.E. Novel synthesis of porous aluminium and its application in hydrogen storage. J. Alloys Compd. 2017, 702, 309–317. [Google Scholar] [CrossRef] [Green Version]
- Huang, J.; Yan, Y.; Ouyang, L.; Wang, H.; Zhu, M. Dehydrogenation mechanism of LiBH4 by Poly(methyl methacrylate). J. Alloys Compd. 2015, 645, S100–S102. [Google Scholar] [CrossRef]
- Plerdsranoy, P.; Wiset, N.; Milanese, C.; Laipple, D.; Marini, A.; Klassen, T.; Dornheim, M.; Gosalawit-Utke, R. Improvement of thermal stability and reduction of LiBH4/polymer host interaction of nanoconfined LiBH4 for reversible hydrogen storage. Int. J. Hydrogen Energy 2015, 40, 392–402. [Google Scholar] [CrossRef]
- Fan, Y.; Chen, D.; Yuan, Z.; Chen, Q.; Fan, G.; Zhao, D.; Liu, B. Flexible, water-resistant and air-stable LiBH4 nanoparticles loaded melamine foam with improved dehydrogenation. Front. Chem. 2020, 8, 1–9. [Google Scholar] [CrossRef] [Green Version]
- Xu, X.; Zang, L.; Zhao, Y.; Liu, Y.; Wang, Y.; Jiao, L. Enhanced dehydrogenation performance of LiBH4 by confinement in porous NiMnO3 microspheres. Int. J. Hydrogen Energy 2017, 42, 25824–25830. [Google Scholar] [CrossRef]
- Xu, X.; Zang, L.; Zhao, Y.; Zhao, Y.; Wang, Y.; Jiao, L. Hydrogen storage behavior of LiBH4 improved by the confinement of hierarchical porous ZnO/ZnCo2O4 nanoparticles. J. Power Sources 2017, 359, 134–141. [Google Scholar] [CrossRef]
- Zang, L.; Sun, W.; Liu, S.; Huang, Y.; Yuan, H.; Tao, Z.; Wang, Y. Enhanced hydrogen storage properties and reversibility of LiBH4 confined in two-dimensional Ti3C2. ACS Appl. Mater. Interfaces 2018, 10, 19598–19604. [Google Scholar] [CrossRef]
- Chen, X.; Li, Z.; Zhang, Y.; Liu, D.; Wang, C.; Li, Y.; Si, T.; Zhang, Q. Enhanced low-temperature hydrogen storage in nanoporous Ni-based alloy supported LiBH4. Front. Chem. 2020, 8, 1–8. [Google Scholar] [CrossRef] [PubMed]
- Kim, S.; Song, H.; Kim, C. Nanoconfinement effects of MCM-41 on the thermal decomposition of metal borohydrides. Anal. Sci. Technol. 2018, 31, 1–6. [Google Scholar] [CrossRef]
- Wang, T.; Aguey-Zinsou, K.F. Controlling the growth of LiBH4 nanoparticles for hydrogen storage. Energy Technol. 2019, 7, 1–9. [Google Scholar] [CrossRef]
- Yao, Q.; Lu, Z.-H.; Zhang, R.; Zhang, S.; Chen, X.; Jiang, H.-L. A noble-metal-free nanocatalyst for highly efficient and complete hydrogen evolution from N2H4BH3. J. Mater. Chem. A 2018, 6, 4386–4393. [Google Scholar] [CrossRef]
- Lai, Q.; Wang, T.; Sun, Y.; Aguey-Zinsou, K. Rational design of nanosized light elements for hydrogen storage: Classes, synthesis, characterization, and properties. Adv. Mater. Technol. 2018, 3, 1700298. [Google Scholar] [CrossRef]
- Mao, J.; Gregory, D.H. Recent advances in the use of sodium borohydride as a solid state hydrogen store. Energies 2015, 8, 430–453. [Google Scholar] [CrossRef]
- Urgnani, J.; Torres, F.J.; Palumbo, M.; Baricco, M. Hydrogen release from solid state NaBH4. Int. J. Hydrogen Energy 2008, 33, 3111–3115. [Google Scholar] [CrossRef]
- Frankcombe, T.J. Proposed mechanisms for the catalytic activity of Ti in NaAlH4. Chem. Rev. 2012, 112, 2164–2178. [Google Scholar] [CrossRef] [PubMed]
- de Jongh, P.E.; Adelhelm, P. Nanosizing and nanoconfinement: New strategies towards meeting hydrogen storage goals. ChemSusChem 2010, 3, 1332–1348. [Google Scholar] [CrossRef] [PubMed]
- Vajo, J.J.; Salguero, T.T.; Gross, A.F.; Skeith, S.L.; Olson, G.L. Thermodynamic destabilization and reaction kinetics in light metal hydride systems. J. Alloys Compd. 2007, 446–447, 409–414. [Google Scholar] [CrossRef]
- Llamas-Jansa, I.; Aliouane, N.; Deledda, S.; Fonneløp, J.E.; Frommen, C.; Humphries, T.; Lieutenant, K.; Sartori, S.; Sørby, M.H.; Hauback, B.C. Chloride substitution induced by mechano-chemical reactions between NaBH4 and transition metal chlorides. J. Alloys Compd. 2012, 530, 186–192. [Google Scholar] [CrossRef]
- Kalantzopoulos, G.N.; Guzik, M.N.; Deledda, S.; Heyn, R.H.; Muller, J.; Hauback, B.C. Destabilization effect of transition metal fluorides on sodium borohydride. Phys. Chem. Chem. Phys. 2014, 16, 20483–20491. [Google Scholar] [CrossRef] [PubMed]
- Llamas Jansa, I.; Kalantzopoulos, G.N.; Nordholm, K.; Hauback, B.C. Destabilization of NaBH4 by transition metal fluorides. Molecules 2020, 25, 780. [Google Scholar] [CrossRef] [PubMed] [Green Version]
- Zhao, N.; Zou, J.; Zeng, X.; Ding, W. Mechanisms of partial hydrogen sorption reversibility in a 3NaBH4/ScF3 composite. RSC Adv. 2018, 8, 9211–9217. [Google Scholar] [CrossRef] [Green Version]
- Huang, T.; Zou, J.; Zhao, N.; Zeng, X.; Ding, W. Reversible hydrogen storage system of 3NaBH4-0.5ScF3-0.5YF3: The synergistic effect of ScF3 and YF3. J. Alloys Compd. 2019, 791, 1270–1276. [Google Scholar] [CrossRef]
- Kumar, S.; Singh, A.; Nakajima, K.; Jain, A.; Miyaoka, H.; Ichikawa, T.; Dey, G.K.; Kojima, Y. Improved hydrogen release from magnesium borohydride by ZrCl4 additive. Int. J. Hydrogen Energy 2017, 42, 22342–22347. [Google Scholar] [CrossRef]
- Mao, J.; Gu, Q.; Guo, Z.; Liu, H.K. Sodium borohydride hydrazinates: Synthesis, crystal structures, and thermal decomposition behavior. J. Mater. Chem. A 2015, 3, 11269–11276. [Google Scholar] [CrossRef] [Green Version]
- Johnson, S.R.; David, W.I.F.; Royse, D.M.; Sommariva, M.; Tang, C.Y.; Fabbiani, F.P.A.; Jones, M.O.; Edwards, P.P. The monoammoniate of lithium borohydride, Li(NH3)BH4: An effective ammonia storage compound. Chem. Asian J. 2009, 4, 849–854. [Google Scholar] [CrossRef] [PubMed]
- Soloveichik, G.; Her, J.-H.; Stephens, P.W.; Gao, Y.; Rijssenbeek, J.; Andrus, M.; Zhao, J.-C. Ammine magnesium borohydride complex as a new material for hydrogen storage: Structure and properties of Mg(BH4)2 ·2NH3. Inorg. Chem. 2008, 47, 4290–4298. [Google Scholar] [CrossRef] [PubMed]
- Chu, H.; Wu, G.; Xiong, Z.; Guo, J.; He, T.; Chen, P. Structure and hydrogen storage properties of calcium borohydride diammoniate. Chem. Mater. 2010, 22, 6021–6028. [Google Scholar] [CrossRef]
- Gu, Q.; Gao, L.; Guo, Y.; Tan, Y.; Tang, Z.; Wallwork, K.S.; Zhang, F.; Yu, X. Structure and decomposition of zinc borohydride ammonia adduct: Towards a pure hydrogen release. Energy Environ. Sci. 2012, 5, 7590. [Google Scholar] [CrossRef] [Green Version]
- He, T.; Wu, H.; Wu, G.; Wang, J.; Zhou, W.; Xiong, Z.; Chen, J.; Zhang, T.; Chen, P. Borohydride hydrazinates: High hydrogen content materials for hydrogen storage. Energy Environ. Sci. 2012, 5, 5686–5689. [Google Scholar] [CrossRef]
- He, T.; Wu, H.; Chen, J.; Zhou, W.; Wu, G.; Xiong, Z.; Zhang, T.; Chen, P. Alkali and alkaline-earth metal borohydride hydrazinates: Synthesis, structures and dehydrogenation. Phys. Chem. Chem. Phys. 2013, 15, 10487. [Google Scholar] [CrossRef]
- Roedern, E.; Jensen, T.R. Synthesis, structures and dehydrogenation properties of zinc borohydride ethylenediamine complexes. ChemistrySelect 2016, 1, 752–755. [Google Scholar] [CrossRef]
- Wang, M.; Ouyang, L.; Peng, C.; Zhu, X.; Zhu, W.; Shao, H.; Zhu, M. Synthesis and hydrolysis of NaZn(BH4)3 and its ammoniates. J. Mater. Chem. A 2017, 5, 17012–17020. [Google Scholar] [CrossRef]
- Payandeh GharibDoust, S.; Heere, M.; Sørby, M.H.; Ley, M.B.; Ravnsbæk, D.B.; Hauback, B.C.; Černý, R.; Jensen, T.R. Synthesis, structure and properties of new bimetallic sodium and potassium lanthanum borohydrides. Dalt. Trans. 2016, 45, 19002–19011. [Google Scholar] [CrossRef] [PubMed]
- Payandeh GharibDoust, S.; Ravnsbæk, D.B.; Černý, R.; Jensen, T.R. Synthesis, structure and properties of bimetallic sodium rare-earth (RE) borohydrides, NaRE(BH4)4, RE = Ce, Pr, Er or Gd. Dalt. Trans. 2017, 46, 13421–13431. [Google Scholar] [CrossRef] [PubMed]
- Roedern, E.; Lee, Y.-S.; Ley, M.B.; Park, K.; Cho, Y.W.; Skibsted, J.; Jensen, T.R. Solid state synthesis, structural characterization and ionic conductivity of bimetallic alkali-metal yttrium borohydrides MY(BH4)4 (M = Li and Na). J. Mater. Chem. A 2016, 4, 8793–8802. [Google Scholar] [CrossRef]
- Wu, Y.; Qi, Y.; Zheng, J.; Li, X. Synthesis and dehydrogenation properties of NaZn(BH4)3·en and NaZn(BH4)3·2en (en = ethylene diamine). J. Energy Chem. 2020, 42, 233–236. [Google Scholar] [CrossRef] [Green Version]
- Christian, M.L.; Aguey-Zinsou, K.-F. Core–shell strategy leading to high reversible hydrogen storage capacity for NaBH4. ACS Nano 2012, 6, 7739–7751. [Google Scholar] [CrossRef]
- Wang, T.; Aguey-Zinsou, K.-F. Controlling the growth of NaBH4 nanoparticles for hydrogen storage. Int. J. Hydrogen Energy 2020, 45, 2054–2067. [Google Scholar] [CrossRef]
- Wang, T.; Aguey-Zinsou, K.-F. “Surfactant-free” sodium borohydride nanoparticles with enhanced hydrogen desorption properties. ACS Appl. Energy Mater. 2020, 3, 9940–9949. [Google Scholar] [CrossRef]
- Salman, M.S.; Rawal, A.; Aguey-Zinsou, K.-F. Tunable NaBH4 nanostructures revealing structure-dependent hydrogen release. Adv. Energy Sustain. Res. 2021, 2, 2100063. [Google Scholar] [CrossRef]
- Wang, T.; Aguey-Zinsou, K.-F. Direct synthesis of NaBH4 nanoparticles from NaOCH3 for hydrogen storage. Energies 2019, 12, 4428. [Google Scholar] [CrossRef] [Green Version]
- Nakamori, Y.; Li, H.W.; Kikuchi, K.; Aoki, M.; Miwa, K.; Towata, S.; Orimo, S. Thermodynamical stabilities of metal-borohydrides. J. Alloys Compd. 2007, 446–447, 296–300. [Google Scholar] [CrossRef]
- Zavorotynska, O.; El-Kharbachi, A.; Deledda, S.; Hauback, B.C. Recent progress in magnesium borohydride Mg(BH4)2: Fundamentals and applications for energy storage. Int. J. Hydrogen Energy 2016, 41, 14387–14403. [Google Scholar] [CrossRef] [Green Version]
- De Jongh, P.E.; Allendorf, M.; Vajo, J.J.; Zlotea, C. Nanoconfined light metal hydrides for reversible hydrogen storage. MRS Bull. 2013, 38, 488–494. [Google Scholar] [CrossRef]
- Jain, A.; Agarwal, S.; Ichikawa, T. Catalytic tuning of sorption kinetics of lightweight hydrides: A review of the materials and mechanism. Catalysts 2018, 8, 651. [Google Scholar] [CrossRef] [Green Version]
- Juahir, N.; Mustafa, N.S.; Halim Yap, F.A.; Ismail, M. Study on the hydrogen storage properties and reaction mechanism of NaAlH4–Mg(BH4)2 (2:1) with and without TiF3 additive. Int. J. Hydrogen Energy 2015, 40, 7628–7635. [Google Scholar] [CrossRef]
- Bai, Y.; Pei, Z.; Wu, F.; Wu, C. Role of metal electronegativity in the dehydrogenation thermodynamics and kinetics of composite metal borohydride–LiNH2 hydrogen storage materials. ACS Appl. Mater. Interfaces 2018, 10, 9514–9521. [Google Scholar] [CrossRef]
- Morelle, F.; Jepsen, L.H.; Jensen, T.R.; Sharma, M.; Hagemann, H.; Filinchuk, Y. Reaction Pathways in Ca(BH4)2–NaNH2 and Mg(BH4)2–NaNH2 hydrogen-rich systems. J. Phys. Chem. C 2016, 120, 8428–8435. [Google Scholar] [CrossRef]
- Zheng, J.; Xiao, X.; Zhang, L.; He, Y.; Li, S.; Ge, H.; Chen, L. Study on the dehydrogenation properties and reversibility of Mg(BH4)2AlH3 composite under moderate conditions. Int. J. Hydrogen Energy 2017, 42, 8050–8056. [Google Scholar] [CrossRef]
- Zheng, J.; Xiao, X.; Zhang, L.; Li, S.; Ge, H.; Chen, L. Facile synthesis of bowl-like 3D Mg(BH4)2–NaBH4–fluorographene composite with unexpected superior dehydrogenation performances. J. Mater. Chem. A 2017, 5, 9723–9732. [Google Scholar] [CrossRef]
- Zheng, J.; Xiao, X.; He, Y.; Chen, M.; Liu, M.; Li, S.; Chen, L. Enhanced reversible hydrogen desorption properties and mechanism of Mg(BH4)2-AlH3-LiH composite. J. Alloys Compd. 2018, 762, 548–554. [Google Scholar] [CrossRef]
- Gigante, A.; Leick, N.; Lipton, A.S.; Tran, B.; Strange, N.A.; Bowden, M.; Martinez, M.B.; Moury, R.; Gennett, T.; Hagemann, H.; et al. Thermal conversion of unsolvated Mg(B3H8)2 to BH4– in the presence of MgH2. ACS Appl. Energy Mater. 2021, 4, 3737–3747. [Google Scholar] [CrossRef]
- Moury, R.; Gigante, A.; Remhof, A.; Roedern, E.; Hagemann, H. Experimental investigation of Mg(B3H8)2 dimensionality, materials for energy storage applications. Dalt. Trans. 2020, 49, 12168–12173. [Google Scholar] [CrossRef] [PubMed]
- Han, M.; Zhao, Q.; Zhu, Z.; Hu, Y.; Tao, Z.; Chen, J. The enhanced hydrogen storage of micro-nanostructured hybrids of Mg(BH4)2–carbon nanotubes. Nanoscale 2015, 7, 18305–18311. [Google Scholar] [CrossRef] [PubMed]
- Jiang, Z.; Yuan, J.; Han, H.; Wu, Y. Effect of carbon nanotubes on the microstructural evolution and hydrogen storage properties of Mg(BH4)2. J. Alloys Compd. 2018, 743, 11–16. [Google Scholar] [CrossRef]
- Wahab, M.A.; Jia, Y.; Yang, D.; Zhao, H.; Yao, X. Enhanced hydrogen desorption from Mg(BH4)2 by combining nanoconfinement and a Ni catalyst. J. Mater. Chem. A 2013, 1, 3471–3478. [Google Scholar] [CrossRef]
- Nale, A.; Pendolino, F.; Maddalena, A.; Colombo, P. Enhanced hydrogen release of metal borohydrides M(BH4)n (M = Li, Na, Mg, Ca) mixed with reduced graphene oxide. Int. J. Hydrogen Energy 2016, 41, 11225–11231. [Google Scholar] [CrossRef]
- Yuan, J.; Huang, H.; Jiang, Z.; Lv, Y.; Liu, B.; Zhang, B.; Yan, Y.; Wu, Y. Ni-doped carbon nanotube-Mg(BH4)2 composites for hydrogen storage. ACS Appl. Nano Mater. 2021, 4, 1604–1612. [Google Scholar] [CrossRef]
- Saldan, I.; Frommen, C.; Llamas-Jansa, I.; Kalantzopoulos, G.N.; Hino, S.; Arstad, B.; Heyn, R.H.; Zavorotynska, O.; Deledda, S.; Sørby, M.H.; et al. Hydrogen storage properties of γ–Mg(BH4)2 modified by MoO3 and TiO2. Int. J. Hydrogen Energy 2015, 40, 12286–12293. [Google Scholar] [CrossRef]
- Zavorotynska, O.; Saldan, I.; Hino, S.; Humphries, T.D.; Deledda, S.; Hauback, B.C. Hydrogen cycling in γ-Mg(BH4)2 with cobalt-based additives. J. Mater. Chem. A 2015, 3, 6592–6602. [Google Scholar] [CrossRef] [Green Version]
- Zavorotynska, O.; Deledda, S.; Vitillo, J.G.; Saldan, I.; Guzik, M.N.; Baricco, M.; Walmsley, J.C.; Muller, J.; Hauback, B.C. Combined X-ray and raman studies on the effect of cobalt additives on the decomposition of magnesium borohydride. Energies 2015, 8, 9173–9190. [Google Scholar] [CrossRef] [Green Version]
- Heere, M.; Zavorotynska, O.; Deledda, S.; Sørby, M.H.; Book, D.; Steriotis, T.; Hauback, B.C. Effect of additives, ball milling and isotopic exchange in porous magnesium borohydride. RSC Adv. 2018, 8, 27645–27653. [Google Scholar] [CrossRef] [Green Version]
- Wang, X.; Xiao, X.; Zheng, J.; Hang, Z.; Lin, W.; Yao, Z.; Zhang, M.; Chen, L. The dehydrogenation kinetics and reversibility improvements of Mg(BH4)2 doped with Ti nano-particles under mild conditions. Int. J. Hydrogen Energy 2021, 46, 23737–23747. [Google Scholar] [CrossRef]
- Zheng, J.; Wang, X.; Xiao, X.; Cheng, H.; Zhang, L.; Chen, L. Improved reversible dehydrogenation properties of Mg(BH4)2 catalyzed by dual-cation transition metal fluorides K2TiF6 and K2NbF7. Chem. Eng. J. 2021, 412, 128738. [Google Scholar] [CrossRef]
- Li, Y.; Liu, Y.; Zhang, X.; Yang, Y.; Gao, M.; Pan, H. Hydrogen storage properties and mechanisms of a Mg(BH4)2·2NH3-NaAlH4 combination system. Int. J. Hydrogen Energy 2016, 41, 2788–2796. [Google Scholar] [CrossRef]
- Leng, H.; Xu, J.; Jiang, J.; Xiao, H.; Li, Q.; Chou, K.C. Improved dehydrogenation properties of Mg(BH4)2·2NH3 combined with LiAlH4. Int. J. Hydrogen Energy 2015, 40, 8362–8367. [Google Scholar] [CrossRef]
- Li, Y.; Liu, Y.; Zhang, X.; Zhou, D.; Lu, Y.; Gao, M.; Pan, H. An ultrasound-assisted wet-chemistry approach towards uniform Mg(BH4)2·6NH3 nanoparticles with improved dehydrogenation properties. J. Mater. Chem. A 2016, 4, 8366–8373. [Google Scholar] [CrossRef]
- Yang, Y.; Liu, Y.; Li, Y.; Zhang, X.; Gao, M.; Pan, H. Towards the endothermic dehydrogenation of nanoconfined magnesium borohydride ammoniate. J. Mater. Chem. A 2015, 3, 11057–11065. [Google Scholar] [CrossRef]
- Yang, Y.; Liu, Y.; Li, Y.; Gao, M.; Pan, H. Fluorine-substituted Mg(BH4)2·2NH3 with improved dehydrogenation properties for hydrogen storage. J. Mater. Chem. A 2015, 3, 570–578. [Google Scholar] [CrossRef]
- Hansen, B.R.S.; Paskevicius, M.; Li, H.-W.; Akiba, E.; Jensen, T.R. Metal boranes: Progress and applications. Coord. Chem. Rev. 2016, 323, 60–70. [Google Scholar] [CrossRef]
- Chu, H.; Qiu, S.; Zou, Y.; Xiang, C.; Zhang, H.; Xu, F.; Sun, L.; Zhou, H. Improvement on hydrogen desorption performance of calcium borohydride diammoniate doped with transition metal chlorides. J. Phys. Chem. C 2014, 119, 913–918. [Google Scholar] [CrossRef]
- Chen, J.; Chua, Y.S.; Wu, H.; Xiong, Z.; He, T.; Zhou, W.; Ju, X.; Yang, M.; Wu, G.; Chen, P. Synthesis, structures and dehydrogenation of magnesium borohydride–ethylenediamine composites. Int. J. Hydrogen Energy 2015, 40, 412–419. [Google Scholar] [CrossRef]
- Li, Z.; He, T.; Wu, G.; Ju, X.; Chen, P. The synthesis, structure and dehydrogenation of calcium borohydride hydrazinates. Int. J. Hydrogen Energy 2015, 40, 5333–5339. [Google Scholar] [CrossRef]
- Wu, H.; Zhou, X.; Rodriguez, E.E.; Zhou, W.; Udovic, T.J.; Yildirim, T.; Rush, J.J. A new family of metal borohydride guanidinate complexes: Synthesis, structures and hydrogen-storage properties. J. Solid State Chem. 2016, 242, 186–192. [Google Scholar] [CrossRef] [Green Version]
- Chong, M.; Autrey, T.; Jensen, C.M. Lewis base complexes of magnesium borohydride: Enhanced kinetics and product selectivity upon hydrogen release. Inorganics 2017, 5, 89. [Google Scholar] [CrossRef] [Green Version]
- Lai, Q.; Aguey-Zinsou, K.F. Destabilisation of Ca(BH4)2 and Mg(BH4)2: Via confinement in nanoporous Cu2S hollow spheres. Sustain. Energy Fuels 2017, 1, 1308–1319. [Google Scholar] [CrossRef]
- Lai, Q.; Pratthana, C.; Yang, Y.; Rawal, A.; Aguey-Zinsou, K.-F. Nanoconfinement of complex borohydrides for hydrogen storage. ACS Appl. Nano Mater. 2021, 4, 973–978. [Google Scholar] [CrossRef]
- Schneemann, A.; Wan, L.F.; Lipton, A.S.; Liu, Y.-S.; Snider, J.L.; Baker, A.A.; Sugar, J.D.; Spataru, C.D.; Guo, J.; Autrey, T.S.; et al. Nanoconfinement of molecular magnesium borohydride captured in a bipyridine-functionalized Metal–Organic Framework. ACS Nano 2020, 14, 10294–10304. [Google Scholar] [CrossRef] [PubMed]
- Wang, X.; Xiao, X.; Zheng, J.; Huang, X.; Chen, M.; Chen, L. In-situ synthesis of amorphous Mg(BH4)2 and chloride composite modified by NbF5 for superior reversible hydrogen storage properties. Int. J. Hydrogen Energy 2020, 45, 2044–2053. [Google Scholar] [CrossRef]
- Sulaiman, N.N.; Ismail, M.; Timmiati, S.N.; Lim, K.L. Improved hydrogen storage performances of LiAlH4 + Mg(BH4)2 composite with TiF3 addition. Int. J. Energy Res. 2021, 45, 2882–2898. [Google Scholar] [CrossRef]
- Yuan, J.; Chen, J.; Huang, H.; Lv, Y.; Liu, B.; Li, Z.; Zhang, B.; Lv, W.; Wu, Y. Enhanced hydrogen storage properties of NaBH4–Mg(BH4)2 composites by NdF3 addition. Prog. Nat. Sci. Mater. Int. 2021. [Google Scholar] [CrossRef]
- Wahab, M.A.; Young, D.J.; Karim, A.; Fawzia, S.; Beltramini, J.N. Low-temperature hydrogen desorption from Mg(BH4)2 catalysed by ultrafine Ni nanoparticles in a mesoporous carbon matrix. Int. J. Hydrogen Energy 2016, 41, 20573–20582. [Google Scholar] [CrossRef]
- Clémençon, D.; Davoisne, C.; Chotard, J.N.; Janot, R. Enhancement of the hydrogen release of Mg(BH4)2 by concomitant effects of nano-confinement and catalysis. Int. J. Hydrogen Energy 2019, 44, 4253–4262. [Google Scholar] [CrossRef]
- Leick, N.; Strange, N.A.; Schneemann, A.; Stavila, V.; Gross, K.; Washton, N.; Settle, A.; Martinez, M.B.; Gennett, T.; Christensen, S.T. Al2O3 atomic layer deposition on nanostructured γ-Mg(BH4)2 for H2 storage. ACS Appl. Energy Mater. 2021, 4, 1150–1162. [Google Scholar] [CrossRef]
- Zheng, J.; Yao, Z.; Xiao, X.; Wang, X.; He, J.; Chen, M.; Cheng, H.; Zhang, L.; Chen, L. Enhanced hydrogen storage properties of high-loading nanoconfined LiBH4–Mg(BH4)2 composites with porous hollow carbon nanospheres. Int. J. Hydrogen Energy 2021, 46, 852–864. [Google Scholar] [CrossRef]
- Javadian, P.; Sheppard, D.A.; Buckley, C.E.; Jensen, T.R. Hydrogen storage properties of nanoconfined LiBH4-Ca(BH4)2. Nano Energy 2015, 11, 96–103. [Google Scholar] [CrossRef]
- Zheng, J.; Cheng, H.; Wang, X.; Chen, M.; Xiao, X.; Chen, L. LiAlH4 as a “Microlighter” on the fluorographite surface triggering the dehydrogenation of Mg(BH4)2: Toward more than 7 wt % hydrogen release below 70 °C. ACS Appl. Energy Mater. 2020, 3, 3033–3041. [Google Scholar] [CrossRef]
- Petit, J.F.; Miele, P.; Demirci, U.B. Ammonia borane H3N-BH3 for solid-state chemical hydrogen storage: Different samples with different thermal behaviors. Int. J. Hydrogen Energy 2016, 41, 15462–15470. [Google Scholar] [CrossRef]
- Nakagawa, Y.; Zhang, T.; Kitamura, M.; Isobe, S.; Hino, S.; Hashimoto, N.; Ohnuki, S. A systematic study of the effects of metal chloride additives on H2 desorption properties of ammonia borane. J. Chem. Eng. Data 2016, 61, 1924–1929. [Google Scholar] [CrossRef]
- Simagina, V.I.; Vernikovskaya, N.V.; Komova, O.V.; Kayl, N.L.; Netskina, O.V.; Odegova, G.V. Experimental and modeling study of ammonia borane-based hydrogen storage systems. Chem. Eng. J. 2017, 329, 156–164. [Google Scholar] [CrossRef]
- Shin, S.; Jin, J.H.; Jung, J. Thermolytic dehydrogenation of cotton-structured SiO2-Ammonia borane nanocomposite. J. Ind. Eng. Chem. 2020, 88, 278–284. [Google Scholar] [CrossRef]
- Ergüven, H.; Kantürk Figen, A.; Pişkin, S. Ammonia borane–boron composites for hydrogen release: Thermolysis kinetics. Energy Sources Part A Recover Util. Environ. Eff. 2017, 39, 613–617. [Google Scholar] [CrossRef]
- Gangal, A.; Edla, R.; Manna, J.; Sharma, P. Effect of misch metal nanoparticles on thermal decomposition of ammonia borane. J. Res. Nanotechnol. 2015, 2015, 1–8. [Google Scholar] [CrossRef] [Green Version]
- Biliškov, N.; Vojta, D.; Kótai, L.; Szilágyi, I.M.; Hunyadi, D.; Pasinszki, T.; Flinčec Grgac, S.; Borgschulte, A.; Züttel, A. High influence of potassium bromide on thermal decomposition of ammonia borane. J. Phys. Chem. C 2016, 120, 25276–25288. [Google Scholar] [CrossRef] [Green Version]
- Huang, J.; Tan, Y.; Gu, Q.; Ouyang, L.; Yu, X.; Zhu, M. Ammonia borane modified zirconium borohydride octaammoniate with enhanced dehydrogenation properties. J. Mater. Chem. A 2015, 3, 5299–5304. [Google Scholar] [CrossRef]
- Kim, G.J.; Boone, A.M.; Chesnut, M.; Shin, J.H.; Jung, J.; Hwang, H.T. Enhanced thermal dehydrogenation of ammonia borane by d-mannitol. Ind. Eng. Chem. Res. 2020, 59, 620–626. [Google Scholar] [CrossRef]
- Kim, G.J.; Hunt, S.G.; Hwang, H.T. Effect of maleic acid on onset temperature and H2 release kinetics for thermal dehydrogenation of ammonia borane. Int. J. Hydrogen Energy 2020, 45, 33751–33758. [Google Scholar] [CrossRef]
- Shin, S.; Jin, J.H.; Jung, J. Sugar acid–assisted thermolysis of all-solid-state ammonia borane hydrogen fuel. Energy Technol. 2020, 8, 1–7. [Google Scholar] [CrossRef]
- Roy, B.; Manna, J.; Sharma, P. Effect of Ni-alloys on thermal decomposition of ammonia borane. J. Alloys Compd. 2015, 645, S234–S238. [Google Scholar] [CrossRef]
- Luo, J.; Wang, J.; Feng, X.; Cai, J.; Yao, W.; Song, J.; Chen, C.; Luo, D. Mechanistic insight into the promoting effect of magnesium nickel hydride on the dehydrogenation of ammonia borane. Int. J. Hydrogen Energy 2018, 43, 1681–1690. [Google Scholar] [CrossRef]
- Wan, L.; Chen, J.; Tan, Y.; Gu, Q.; Yu, X. Ammonia borane destabilized by aluminium hydride: A mutual enhancement for hydrogen release. Int. J. Hydrogen Energy 2015, 40, 1047–1053. [Google Scholar] [CrossRef]
- Dovgaliuk, I.; Le Duff, C.S.; Robeyns, K.; Devillers, M.; Filinchuk, Y. Mild dehydrogenation of ammonia borane complexed with aluminum borohydride. Chem. Mater. 2015, 27, 768–777. [Google Scholar] [CrossRef]
- Huang, H.; Wang, C.; Li, Q.; Wang, R.; Yang, Y.; Muhetaer, A.; Huang, F.; Han, B.; Xu, D. Efficient and full-spectrum photothermal dehydrogenation of ammonia borane for low-temperature release of hydrogen. Adv. Funct. Mater. 2021, 31, 1–9. [Google Scholar] [CrossRef]
- Castilla-Martinez, C.A.; Moury, R.; Demirci, U.B. Amidoboranes and hydrazinidoboranes: State of the art, potential for hydrogen storage, and other prospects. Int. J. Hydrogen Energy 2020, 45, 30731–30755. [Google Scholar] [CrossRef]
- Milanović, I.; Biliškov, N. Mechanochemical pretreatment of ammonia borane: A new procedure for sodium amidoborane synthesis. Int. J. Hydrogen Energy 2020, 45, 7938–7946. [Google Scholar] [CrossRef]
- Lee, C.H.; Nakagawa, Y.; Isobe, S.; Hashimoto, N.; Sugino, S.; Miyaoka, H.; Ichikawa, T. Synthesis of sodium-magnesium amidoborane by sodium amide: An investigation of functional properties for hydrogen/ammonia storage. J. Alloys Compd. 2019, 801, 645–650. [Google Scholar] [CrossRef]
- Wu, C.; Wu, G.; Xiong, Z.; David, W.I.F.; Ryan, K.R.; Jones, M.O.; Edwards, P.P.; Chu, H.; Chen, P. Stepwise phase transition in the formation of lithium amidoborane. Inorg. Chem. 2010, 49, 4319–4323. [Google Scholar] [CrossRef] [PubMed]
- Liu, X.; Wang, S.; Wu, Y.; Li, Z.; Jiang, L.; Guo, X.; Ye, J. Dehydrogenation properties of two phases of LiNH2BH3. Int. J. Hydrogen Energy 2019, 5, 1–8. [Google Scholar] [CrossRef]
- Ghaani, M.R.; Catti, M. Dehydrogenation properties of the LiNH2BH3/MgH2 and LiNH2BH3/LiBH4 bi-component hydride systems for hydrogen storage applications. Mater. Renew. Sustain. Energy 2018, 7, 1–6. [Google Scholar] [CrossRef] [Green Version]
- Owarzany, R.; Jaroń, T.; Leszczyński, P.J.; Fijalkowski, K.J.; Grochala, W. Amidoboranes of rubidium and caesium: The last missing members of the alkali metal amidoborane family. Dalt. Trans. 2017, 46, 16315–16320. [Google Scholar] [CrossRef]
- Kazakov, I.V.; Butlak, A.V.; Shelyganov, P.A.; Suslonov, V.V.; Timoshkin, A.Y. Reversible structural transformations of rubidium and cesium amidoboranes. Polyhedron 2017, 127, 186–190. [Google Scholar] [CrossRef]
- Davydova, E.I.; Lisovenko, A.S.; Timoshkin, A.Y. Complex beryllium amidoboranes: Structures, stability, and evaluation of their potential as hydrogen storage materials. J. Comput. Chem. 2017, 38, 401–405. [Google Scholar] [CrossRef] [PubMed]
- Shcherbina, N.A.; Kazakov, I.V.; Timoshkin, A.Y. Synthesis and characterization of barium amidoborane. Russ. J. Gen. Chem. 2017, 87, 2875–2877. [Google Scholar] [CrossRef]
- Dovgaliuk, I.; Jepsen, L.H.; Safin, D.A.; Łodziana, Z.; Dyadkin, V.; Jensen, T.R.; Devillers, M.; Filinchuk, Y. A composite of complex and chemical hydrides yields the first Al-based amidoborane with improved hydrogen storage properties. Chem. Eur. J. 2015, 21, 14562–14570. [Google Scholar] [CrossRef] [PubMed]
- Nakagawa, Y.; Shinzato, K.; Nakagawa, T.; Nakajima, K.; Isobe, S.; Goshome, K.; Miyaoka, H.; Ichikawa, T. Synthesis, structural characterization, and hydrogen desorption properties of Na[Al(NH2BH3)4]. Int. J. Hydrogen Energy 2017, 42, 6173–6180. [Google Scholar] [CrossRef] [Green Version]
- Milanović, I.; Biliškov, N.; Užarević, K.; Lukin, S.; Etter, M.; Halasz, I. Mechanochemical synthesis and thermal dehydrogenation of novel calcium-containing bimetallic amidoboranes. ACS Sustain. Chem. Eng. 2021, 9, 2089–2099. [Google Scholar] [CrossRef]
- Chernysheva, A.M.; Shelyganov, P.A.; Kazakov, I.V.; Timoshkin, A.Y. Complex amidoboranes M2[M1(NH2BH3)4] (M1 = Al, Ga; M2 = Li, Na, K, Rb, Cs). Russ. J. Gen. Chem. 2017, 87, 665–669. [Google Scholar] [CrossRef]
- Yang, J.; Beaumont, P.R.; Humphries, T.D.; Jensen, C.M.; Li, X. Efficient synthesis of an aluminum amidoborane ammoniate. Energies 2015, 8, 9107–9116. [Google Scholar] [CrossRef] [Green Version]
- He, T.; Wu, H.; Wu, G.; Li, Z.; Zhou, W.; Ju, X.; Xie, D.; Chen, P. Lithium amidoborane hydrazinates: Synthesis, structure and hydrogen storage properties. J. Mater. Chem. A 2015, 3, 10100–10106. [Google Scholar] [CrossRef]
- Li, Z.; He, T.; Wu, G.; Chen, W.; Chua, Y.S.; Guo, J.; Xie, D.; Ju, X.; Chen, P. Synthesis, structure and the dehydrogenation mechanism of calcium amidoborane hydrazinates. Phys. Chem. Chem. Phys. 2016, 18, 244–251. [Google Scholar] [CrossRef]
- Jørgensen, M.; Lee, Y.-S.; Bjerring, M.; Jepsen, L.H.; Akbey, Ü.; Cho, Y.W.; Jensen, T.R. Disorder induced polymorphic transitions in the high hydrogen density compound Sr(BH4)2(NH3BH3)2. Dalt. Trans. 2018, 47, 16737–16746. [Google Scholar] [CrossRef]
- Valero-Pedraza, M.J.; Gascón, V.; Carreón, M.A.; Leardini, F.; Ares, J.R.; Martín, Á.; Sánchez-Sánchez, M.; Banãres, M.A. Operando Raman-mass spectrometry investigation of hydrogen release by thermolysis of ammonia borane confined in mesoporous materials. Microporous Mesoporous Mater. 2016, 226, 454–465. [Google Scholar] [CrossRef]
- Sullivan, J.A.; Herron, R.; Phillips, A.D. Towards an understanding of the beneficial effect of mesoporous materials on the dehydrogenation characteristics of NH3BH3. Appl. Catal. B Environ. 2017, 201, 182–188. [Google Scholar] [CrossRef] [Green Version]
- Rueda, M.; Sanz-Moral, L.M.; Segovia, J.J.; Martín, Á. Improvement of the kinetics of hydrogen release from ammonia borane confined in silica aerogel. Microporous Mesoporous Mater. 2017, 237, 189–200. [Google Scholar] [CrossRef]
- Roy, B.; Manna, J.; Pal, U.; Hajari, A.; Bishnoi, A.; Sharma, P. An: In situ study on the solid state decomposition of ammonia borane: Unmitigated by-product suppression by a naturally abundant layered clay mineral. Inorg. Chem. Front. 2018, 5, 301–309. [Google Scholar] [CrossRef]
- Feng, Y.; Zhou, X.; Yang, J.; Gao, X.; Yin, L.; Zhao, Y.; Zhang, B. Encapsulation of ammonia borane in Pd/Halloysite nanotubes for efficient thermal dehydrogenation. ACS Sustain. Chem. Eng. 2020, 8, 2122–2129. [Google Scholar] [CrossRef]
- So, S.H.; Jang, J.H.; Sung, S.J.; Yang, S.J.; Nam, K.T.; Park, C.R. Demonstration of the nanosize effect of carbon nanomaterials on the dehydrogenation temperature of ammonia borane. Nanoscale Adv. 2019, 1, 4697–4703. [Google Scholar] [CrossRef] [Green Version]
- Yang, Z.; Zhou, D.; Chen, B.; Liu, Z.; Xia, Q.; Zhu, Y.; Xia, Y. Improved hydrogen release from ammonia borane confined in microporous carbon with narrow pore size distribution. J. Mater. Chem. A 2017, 5, 15395–15400. [Google Scholar] [CrossRef]
- Bravo Diaz, L.; Hanlon, J.M.; Bielewski, M.; Milewska, A.; Gregory, D.H. Ammonia borane based nanocomposites as solid-state hydrogen stores for portable power applications. Energy Technol. 2018, 6, 583–594. [Google Scholar] [CrossRef]
- Cao, Z.; Ouyang, L.; Felderhoff, M.; Zhu, M. Low temperature dehydrogenation properties of ammonia borane within carbon nanotube arrays: A synergistic effect of nanoconfinement and alane. RSC Adv. 2020, 10, 19027–19033. [Google Scholar] [CrossRef]
- Li, Z.; Liu, W.; Yang, H.; Sun, T.; Liu, K.; Wang, Z.; Niu, C. Improved thermal dehydrogenation of ammonia borane by MOF-5. RSC Adv. 2015, 5, 10746–10750. [Google Scholar] [CrossRef]
- Kong, S.; Dai, R.; Li, H.; Sun, W.; Wang, Y. Microwave hydrothermal synthesis of Ni-based Metal-Organic Frameworks and their derived yolk-shell NiO for Li-ion storage and supported ammonia borane for hydrogen desorption. ACS Sustain. Chem. Eng. 2015, 3, 1830–1838. [Google Scholar] [CrossRef]
- Yang, H.; Li, Z.; Liu, K.; Meng, F.; Niu, C. Clean hydrogen release from ammonia borane in a metal-organic framework with unsaturated coordinated Tm3+. J. Phys. Chem. C 2015, 119, 2260–2265. [Google Scholar] [CrossRef]
- Wang, X.; Xie, L.; Huang, K.W.; Lai, Z. A rationally designed amino-borane complex in a metal organic framework: A novel reusable hydrogen storage and size-selective reduction material. Chem. Commun. 2015, 51, 7610–7613. [Google Scholar] [CrossRef] [PubMed] [Green Version]
- Liao, C.W.; Tseng, P.S.; Chang, B.K.; Wang, C.Y. Facilitated hydrogen release kinetics from amine borane functionalization on gate-opening metal-organic framework. Surf. Coatings Technol. 2018, 350, 12–19. [Google Scholar] [CrossRef]
- Chung, J.Y.; Liao, C.W.; Chang, Y.W.; Chang, B.K.; Wang, H.; Li, J.; Wang, C.Y. Influence of Metal-Organic Framework porosity on hydrogen generation from nanoconfined ammonia borane. J. Phys. Chem. C 2017, 121, 27369–27378. [Google Scholar] [CrossRef]
- Wu, Y.J.; Wang, C.Y. Insight into the catalytic effects of open metal sites in Metal-Organic Frameworks on hydride dehydrogenation via nanoconfinement. ACS Sustain. Chem. Eng. 2019, 7, 16013–16025. [Google Scholar] [CrossRef]
- Zhang, L.; Xia, G.; Ge, Y.; Wang, C.; Guo, Z.; Li, X.; Yu, X. Ammonia borane confined by nitrogen-containing carbon nanotubes: Enhanced dehydrogenation properties originating from synergetic catalysis and nanoconfinement. J. Mater. Chem. A 2015, 3, 20494–20499. [Google Scholar] [CrossRef]
- Yang, Z.; Sun, H.; Li, H.; Li, F.; Qijing, H.; Zhang, Y. Enhancing the thermal dehydrogenation properties of ammonia borane (AB) by using monodisperse MnO2 hollow spheres (MHS). J. Alloys Compd. 2019, 781, 111–117. [Google Scholar] [CrossRef]
- Salameh, C.; Moussa, G.; Bruma, A.; Fantozzi, G.; Malo, S.; Miele, P.; Demirci, U.B.; Bernard, S. Robust 3D boron nitride nanoscaffolds for remarkable hydrogen storage capacity from ammonia borane. Energy Technol. 2018, 6, 570–577. [Google Scholar] [CrossRef] [Green Version]
- Richard, J.; Cid, S.L.; Rouquette, J.; Van Der Lee, A.; Bernard, S.; Haines, J. Pressure-induced insertion of ammonia borane in the siliceous zeolite, silicalite-1F. J. Phys. Chem. C 2016, 120, 9334–9340. [Google Scholar] [CrossRef]
- Sun, W.; Li, H.; Wang, Y. Graphene-supported nickel chloride and cobalt chloride nanoparticles as highly efficient catalysts for dehydrogenation of ammonia borane. Int. J. Hydrogen Energy 2015, 40, 15389–15397. [Google Scholar] [CrossRef]
- Champet, S.; Van Den Berg, J.; Szczesny, R.; Godula-Jopek, A.; Gregory, D.H. Nano-inclusion in one step: Spontaneous ice-templating of porous hierarchical nanocomposites for selective hydrogen release. Sustain. Energy Fuels 2019, 3, 396–400. [Google Scholar] [CrossRef] [Green Version]
- Peil, S.; Wisser, D.; Stähle, M.; Roßmann, P.K.; Avadhut, Y.S.; Hartmann, M. Hydrogen release from ammonia borane nanoconfined in Metal-Organic Frameworks with MIL-53 topology. J. Phys. Chem. C 2021, 125, 9990–10000. [Google Scholar] [CrossRef]
- Nathanson, A.S.; Ploszajski, A.R.; Billing, M.; Cook, J.P.; Jenkins, D.W.K.; Headen, T.F.; Kurban, Z.; Lovell, A.; Bennington, S.M. Ammonia borane-polyethylene oxide composite materials for solid hydrogen storage. J. Mater. Chem. A 2015, 3, 3683–3691. [Google Scholar] [CrossRef]
- Ploszajski, A.R.; Billing, M.; Cockcroft, J.K.; Skipper, N.T. Crystalline structure of an ammonia borane-polyethylene oxide cocrystal: A material investigated for its hydrogen storage potential. CrystEngComm 2018, 20, 4436–4440. [Google Scholar] [CrossRef] [Green Version]
- Ploszajski, A.R.; Billing, M.; Nathanson, A.S.; Vickers, M.; Bennington, S.M. Freeze-dried ammonia borane-polyethylene oxide composites: Phase behaviour and hydrogen release. Int. J. Hydrogen Energy 2018, 43, 5645–5656. [Google Scholar] [CrossRef]
- Seemaladinne, R.; Pati, S.; Kharel, K.; Bafana, A.; al-Wahish, A.; Wujcik, E.K.; Günaydın-Şen, Ö. Ammonia borane with polyvinylpyrrolidone as a hydrogen storage material: Comparison of different molecular weights. J. Phys. Chem. Solids 2017, 110, 394–400. [Google Scholar] [CrossRef]
- Alipour, J.; Shoushtari, A.M.; Kaflou, A. Ammonia borane confined by poly(methyl methacrylate)/multiwall carbon nanotube nanofiber composite, as a polymeric hydrogen storage material. J. Mater. Sci. 2015, 50, 3110–3117. [Google Scholar] [CrossRef]
- Roy, B.; Hajari, A.; Manna, J.; Sharma, P. Supported ammonia borane decomposition through enhanced homopolar B-B coupling. Dalt. Trans. 2018, 47, 6570–6579. [Google Scholar] [CrossRef]
- Demirci, U.B. Mechanistic insights into the thermal decomposition of ammonia borane, a material studied for chemical hydrogen storage. Inorg. Chem. Front. 2021, 8, 1900–1930. [Google Scholar] [CrossRef]
- Petit, J.F.; Demirci, U.B. Mechanistic insights into dehydrogenation of partially deuterated ammonia borane NH3BD3 being heating to 200°C. Inorg. Chem. 2019, 58, 489–494. [Google Scholar] [CrossRef]
- Song, Y.; Ma, N.; Ma, X.; Fang, F.; Chen, X.; Guo, Y. Synthesis of ammonia borane nanoparticles and the diammoniate of diborane by direct combination of diborane and ammonia. Chem. Eur. J. 2016, 22, 6228–6233. [Google Scholar] [CrossRef]
- Lai, Q.; Rawal, A.; Quadir, M.Z.; Cazorla, C.; Demirci, U.B.; Aguey-Zinsou, K.F. Nanosizing ammonia borane with nickel: A path toward the direct hydrogen release and uptake of B–N–H systems. Adv. Sustain. Syst. 2018, 2, 1–14. [Google Scholar] [CrossRef]
- Valero-Pedraza, M.J.; Cot, D.; Petit, E.; Aguey-Zinsou, K.F.; Alauzun, J.G.; Demirci, U.B. Ammonia borane nanospheres for hydrogen storage. ACS Appl. Nano Mater. 2019, 2, 1129–1138. [Google Scholar] [CrossRef]
- Pylypko, S.; Petit, J.F.; Ould-Amara, S.; Hdhili, N.; Taihei, A.; Chiriac, R.; Ichikawa, T.; Cretin, M.; Miele, P.; Demirci, U.B. Metal hydride-hydrazine borane: Towards hydrazinidoboranes or composites as hydrogen carriers. Int. J. Hydrogen Energy 2015, 40, 14875–14884. [Google Scholar] [CrossRef]
- Moury, R.; Demirci, U.B.; Ban, V.; Filinchuk, Y.; Ichikawa, T.; Zeng, L.; Goshome, K.; Miele, P. Lithium hydrazinidoborane: A polymorphic material with potential for chemical hydrogen storage. Chem. Mater. 2014, 26, 3249–3255. [Google Scholar] [CrossRef] [Green Version]
- Moury, R.; Demirci, U.B.; Ichikawa, T.; Filinchuk, Y.; Chiriac, R.; Van Der Lee, A.; Miele, P. Sodium hydrazinidoborane: A chemical hydrogen-storage material. ChemSusChem 2013, 6, 667–673. [Google Scholar] [CrossRef] [PubMed]
- Chua, Y.S.; Pei, Q.; Ju, X.; Zhou, W.; Udovic, T.J.; Wu, G.; Xiong, Z.; Chen, P.; Wu, H. Alkali metal hydride modification on hydrazine borane for improved dehydrogenation. J. Phys. Chem. C 2014, 118, 11244–11251. [Google Scholar] [CrossRef]
- Wu, H.; Zhou, W.; Pinkerton, F.E.; Udovic, T.J.; Yildirim, T.; Rush, J.J. Metal hydrazinoborane LiN2H3BH3 and LiN2H3BH3·2N2H4BH3: Crystal structures and high-extent dehydrogenation. Energy Environ. Sci. 2012, 5, 7531. [Google Scholar] [CrossRef]
- Castilla-Martinez, C.A.; Granier, D.; Charmette, C.; Maurin, G.; Yot, P.G.; Demirci, U.B. Rubidium hydrazinidoborane: Synthesis, characterization and hydrogen release properties. Int. J. Hydrogen Energy 2019, 44, 28252–28261. [Google Scholar] [CrossRef]
- Castilla-Martinez, C.A.; Granier, D.; Charmette, C.; Cartier, J.; Yot, P.G.; Demirci, U.B. Cesium hydrazinidoborane, the last of the alkali hydrazinidoboranes, studied as potential hydrogen storage material. Int. J. Hydrogen Energy 2020, 45, 16634–16643. [Google Scholar] [CrossRef]
- Moury, R.; Petit, J.F.; Demirci, U.B.; Ichikawa, T.; Miele, P. Pure hydrogen-generating “doped” sodium hydrazinidoborane. Int. J. Hydrogen Energy 2015, 40, 7475–7482. [Google Scholar] [CrossRef]
- Ould-Amara, S.; Granier, D.; Chiriac, R.; Toche, F.; Yot, P.G.; Demirci, U.B. Lithium hydrazinidoborane ammoniate LiN2H3BH3·0.25NH3, a derivative of hydrazine borane. Materials 2017, 10, 750. [Google Scholar] [CrossRef] [Green Version]
- Ould-Amara, S.; Yadav, V.; Petit, E.; Maurin, G.; Yot, P.G.; Demirci, U.B. Calcium hydrazinidoborane: Synthesis, characterization, and promises for hydrogen storage. Int. J. Hydrogen Energy 2019, 45, 2022–2033. [Google Scholar] [CrossRef]
- Castilla-Martinez, C.A.; Roussignol, L.; Demirci, U.B. Magnesium hydrazinidoborane: Synthesis, characterization and features for solid-state hydrogen storage. Int. J. Hydrogen Energy 2021, 46, 33164–33175. [Google Scholar] [CrossRef]
- Fu, H.; Yang, J.; Wang, X.; Xin, G.; Zheng, J.; Li, X. Preparation and dehydrogenation properties of lithium hydrazidobis(borane) (LiNH(BH3)NH2BH3). Inorg. Chem. 2014, 53, 7334–7339. [Google Scholar] [CrossRef]
- Hajari, A.; Roy, B.; Sharma, P. Metal-free rapid dehydrogenation kinetics and better regeneration yield of ammonia borane. Int. J. Hydrogen Energy 2021, 46, 24214–24224. [Google Scholar] [CrossRef]
- Tan, Y.; Zhang, L.; Chen, X.; Yu, X. Reductive dechlorination of BCl3 for efficient ammonia borane regeneration. Dalt. Trans. 2015, 44, 753–757. [Google Scholar] [CrossRef] [PubMed]
- Nakagawa, T.; Uesato, H.; Burrell, A.K.; Ichikawa, T.; Miyaoka, H.; Davis, B.L.; Kojima, Y. Surface-controlled conversion of ammonia borane from boron nitride. Energies 2020, 13, 5569. [Google Scholar] [CrossRef]

| Material | SSA (m2 g−1) | APS (nm) | TPV (cm3 g−1) | Infiltration Method | Tonset (°C) | Tpeak (°C) | Ea (kJ mol−1) | Byproducts | Ref. |
|---|---|---|---|---|---|---|---|---|---|
| SBA-15 | 609 | 7.8 | 0.96 | THF | 40 | 97 | - | Not detected | [273] |
| SBA-15 | 550 | 6.4 | 0.69 | THF | 40 | 97 | - | B2H6 | |
| SBA-15 | 497 | 4.3 | - | THF | 75 | 90 | - | AB(g) | [274] |
| MCM-41 | 668 | 3.4 | - | THF | 95 | 108 | - | AB(g) | |
| MCF | 217 | 18.0 | - | THF | 75 | 80 | - | AB(g) | |
| Silica aerogel | 887 | 8.7 | 1.94 | THF | 37 | 62 | - | Not reported | [275] |
| Bentonite | 42.4 | - | - | CH3OH | R.T. | 120 | - | Not detected | [276] |
| Pd-halloysite | 48.1 | 2.8 | 0.2 | THF | 60 | 80 | 46 | Not detected | [277] |
| MOF-derived carbon | 2222 | 0.4 | 2.49 | THF | 63 | 72 | 61 | NH3 | [278] |
| Microporous carbon | 1652 | 1.0 | 0.87 | CH3OH | 50 | 86 | 75 | Not detected | [279] |
| AC | - | - | - | Ball milling | 85 | 104 | 34 | NH3, B2H6, B3H6N3 | [280] |
| AC | - | - | - | THF | 96 | 112 | - | NH3 | |
| CMK-5 | 1650 | 4 | 1.69 | THF | 50 | 98 | - | NH3 | [281] |
| MOF-5 | 1032 | - | 0.57 | CH3OH | 60 | 84 | 68.4 | NH3 | [282] |
| Ni-MOF | - | - | - | Ball milling | 70 | 90 | - | Not detected | [283] |
| Tm(BCT) | - | - | - | CH3OH | 60 | 77 | 98.1 | Not detected | [284] |
| UiO-66-NH2 | 976 | - | 0.43 | Et2O | <50 | 78 | - | Not detected | [285] |
| MIL-53-NH2 (Al) | 540 | - | - | THF | 60 | 91 | 38.2 | Not detected | [286] |
| IRMOF-1 | 1060 | 1.3 | 0.43 | CH3OH | <45 | 75 | - | NH3 | [287] |
| IRMOF-10 | 320 | - | 0.18 | CH3OH | 50 | 73 | - | NH3 | |
| UiO-66 | 1010 | 1.1 | 0.67 | CH3OH | <45 | 64 | - | NH3 | |
| UiO-67 | 1920 | - | 0.75 | CH3OH | <50 | 76 | - | NH3 | |
| MIL-53(Al) | 1110 | 1.8 | 0.58 | CH3OH | 65 | 85 | - | NH3 | |
| Cu(BDC) | 550 | 1.3 | - | Hand grinding | <60 | 96 | 101.9 | Not detected | [288] |
| PPy nanotubes | 74.9 | 40 | 0.29 | THF | 48 | 90 | 78.5 | Not detected | [289] |
| MnO2 hollow spheres | 256.9 | 2.4 | 0.47 | THF | 70 | 107 | 68.5 | Not detected | [290] |
| h-BN | 584 | - | 0.75 | THF | >40 | 98 | - | Not detected | [291] |
Publisher’s Note: MDPI stays neutral with regard to jurisdictional claims in published maps and institutional affiliations. |
© 2021 by the authors. Licensee MDPI, Basel, Switzerland. This article is an open access article distributed under the terms and conditions of the Creative Commons Attribution (CC BY) license (https://creativecommons.org/licenses/by/4.0/).
Share and Cite
Castilla-Martinez, C.A.; Moury, R.; Ould-Amara, S.; Demirci, U.B. Destabilization of Boron-Based Compounds for Hydrogen Storage in the Solid-State: Recent Advances. Energies 2021, 14, 7003. https://doi.org/10.3390/en14217003
Castilla-Martinez CA, Moury R, Ould-Amara S, Demirci UB. Destabilization of Boron-Based Compounds for Hydrogen Storage in the Solid-State: Recent Advances. Energies. 2021; 14(21):7003. https://doi.org/10.3390/en14217003
Chicago/Turabian StyleCastilla-Martinez, Carlos A., Romain Moury, Salem Ould-Amara, and Umit B. Demirci. 2021. "Destabilization of Boron-Based Compounds for Hydrogen Storage in the Solid-State: Recent Advances" Energies 14, no. 21: 7003. https://doi.org/10.3390/en14217003








